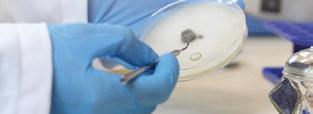
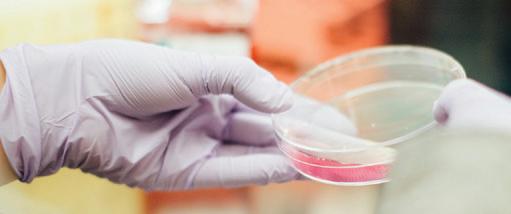

into Development REPORT CeNAT 2023
Transforming Knowledge Centro Nacional de Alta Tecnología



Transforming Knowledge Centro Nacional de Alta Tecnología into Development REPORT CeNAT 2023
303 483
C755c Consejo Nacional de Rectores Centro Nacional de Alta Tecnología
CENAT 2023 report : Transforming Knowledge into Development [Recurso electrónico] / Centro Nacional de Alta Tecnología – Datos electrónicos (1 archivo : 34 mb) -- San José, C R : CONARE - OPES, 2024
ISSN 2215-6933
Formato pdf, (198 páginas )
1 INFORME DE LABORES 2 CIENCIA Y TECNOLOGÍA 3 DESARROLLO CIENTÍFICO Y TECNOLÓGICO 4 CONSEJO NACIONAL DE RECTORES CENTRO NACIONAL DE ALTA TÉCNOLOGÍA 5 COSTA RICA I Título
National Nanotechnology Laboratory (LANOTEC)
Presentation CeNAT Our Areas, Laboratories and Programs
CENIBiot Laboratory
Environmental Management Area Institutional Results Indicators of Institutional Work FunCeNAT and Financial Results Institutional Leadership 4-5 18-37 6-17 38-56 57-72 73-89 90-107 108-124 125-161 162-165 166-173 174-193
National Advanced Computing Collaboratory (CNCA) PRIAS Laboratory
Acronyms

CONARE
CeNAT
PRIAS
LANOTEC
CNCA
CENIBiot
CREATEC
TEC
UCR
UNA
UNED
UTN
Edu-Roam
LACOMET
USAID
BCCR
CCSS
CONICIT
ICE
INA
INEC
MAG
MICITT
MINAE
RREE
FEES
SAF
PILA
UdelaR
CONICET
UBA
CNEA
Univalle
UNI
CNRS
UGA
TGA
FTIR
SEM
TEM
CANAPEP
IJSO
National Council of University Deans
Centro Nacional de Alta Tecnología
PRIAS Laboratory
National Nanotechnology Laboratory
National Advanced Computing Collaboratory
National Center for Biotechnological Innovations
Program for Creativity and Entrepreneurship in High Technology
Costa Rica Institute of Technology
University of Costa Rica
National University
Universidad Estatal a Distancia (State Distance Education University)
National Technical University
Education Roaming
Costa Rican Metrology Laboratory
United States Agency for International Development
Central Bank of Costa Rica
Costa Rica Social Security Fund
National Council for Scientific and Technological Research
Costa Rican Institute of Electricity
National Institute for Learning (INA)
National Institute of Statistics and Census
Ministry of Agriculture and Livestock
Ministry of Science, Technology and Telecommunications
Ministry of Environment and Energy
Ministry of Foreign Affairs and Culture
Special Fund for Higher Education
Agroforestry Systems
La Amistad International Park
University of the Republic of Uruguay
National Council for Scientific and Technical Research
University of Buenos Aires
National Atomic Energy Commission
Universidad del Valle, Colombia
National University of Engineering, Peru
Centre National de la Recherche Scientifique, France
University of Grenoble Alpes, France
Thermogravimetry
Fourier Transform Infrared Spectroscopy
Scanning Electron Microscopy
Transmission Electron Microscopy
National Chamber of Pineapple Producers and Exporters
International Junior Science Olympiad
COLAEIQ
ACOMET
INS
AFM
Latin American Congress of Students of Chemical Engineering and Related Majors
ACOMET Metales y Minerales S.L.
National Insurance Institute
Atomic Force Microscopy
1

QUIMICAM
ECMAR
ICHO
NAVAL
INALVE
FIFCO
ULEAD
NASA
NOAA
USGS
ESA
DLR
ILSI Mesoamerica
STEAM
ALLBIOTECH
DOS PINOS
PINN
CITA
INTA
AECID
TUHH
Chemistry Camp
National Marine-Coastal Science Station
International Chemistry Olympiad
NAVAL United States Geological Survey
Inalve Food Industries
Florida Ice and Farm Company
LEAD University
National Aeronautics and Space Administration
National Oceanic and Atmospheric Administration
United States Geological Survey
European Space Agency
German Space Agency

ILSI Mesoamerica Association

CORBANA
BIOTECH
SEVRI
AOP

Science, Technology, Engineering, Art, and Mathematics
Latin American Network of Young Leaders in Biotechnology
Cooperativa de Productores de Leche Dos Pinos R.L.
Innovation and Human Capital Program for Competitiveness
National Center for Food Science and Technology
National Institute of Innovation and Transfer in Agricultural Technology
Spanish Agency for International Development Cooperation
Hamburg University of Technology, Germany
National Banana Corporation
Biotechnology

Specific Institutional Risk Assessment System
Annual Operational Plan








2

3

Eduardo Sibaja Arias
Director
Centro Nacional de Alta Tecnología
CeNAT contributing to research and innovation for the benefit of the country
25 years have passed since the Government of the Republic (1994-1998) and the Consejo Nacional de Rectores promoted the creation of the Centro Nacional de Alta Tecnología. This scheme was inspired by a model implemented in countries such as Korea, Japan, Malaysia, Singapore, and Israel, which explicitly linked the government, universities, and high-tech companies to form a tripartite alliance focused on scientific-technological research and innovation as driving forces of the economy.
In the midst of this panorama, a dream began to take shape that today, 25 years later, is a reality: the Centro Nacional de Alta Tecnología (CeNAT), a program created by the Consejo Nacional de Rectores (CONARE) in session N°599 of March 2, 1999 as an “interuniversity body specialized in the development of research and postgraduate studies in high-tech areas and the development of linkage and technological innovation projects with the government and business sectors”.
Through these more than two decades, CONARE's CeNAT has developed extensive research experience, thanks to the work of its four laboratories - PRIAS Laboratory, National Nanotechnology Laboratory (LANOTEC), CENIBiot Laboratory, National Advanced Computing Collaboratory (CNCA), and the Environmental Management Area.
All of them focus their work on research and innovation, to transform scientific and technological knowledge into development.
During these years of achievements and challenges, we have implemented accountability instruments that strengthen transparency processes. One of them is the Annual Report that compiles the management of CeNAT and each division, which allows us to measure the degree of efficiency and effectiveness of our work.
In this 2023 Report, we present the institutional management figures. This year, CeNAT recorded 95 projects developed within the framework of the triple helix (academia, government, and private sector), 157 knowledge transfers, 66 scientific publications, technical assistance to more than 9,000 producers, support to 28 applied science research organizations or institutions; support to 45 applied science research companies; support to seven Olympiads and science fairs, and 85,363 science hours in simulations and data processing, among other management indicators.
4


Our work would not be possible without the support of the Consejo Nacional de Rectores (CONARE) and the alliances with strategic partners such as the University of Costa Rica (UCR), the Costa Rica Institute of Technology (TEC), the National University (UNA), the State University for Distance Education (UNED), the National Technical University (UTN), the Ministry of Science, Innovation, Technology and Telecommunications (MICITT), the former National Council for Scientific and Technological Research (CONICIT) -currently Costa Rican Promoter of Innovation and Research-; among many other institutions, companies and research centers of great renown, both national and international.
Presenting this Report and our management results within the framework of the 25th anniversary makes us reflect on maintaining coherence with reality and meeting the demands of these times, while very clearly marking the roadmap.

During this period, CeNAT has been consolidated as a unique center both in Costa Rica and in the region. Our management indicators reflect our commitment to excellence and also challenge us to continue growing on the path of continuous improvement, while contributing to the strengthening of science and technology. In addition, we have been helping to cultivate scientific vocations in future generations as a fundamental country goal.
5



Background of CeNAT



The initiative for the creation of a National High Technology Center in Costa Rica was raised with the support of state universities to attract investment in high technology. It took place in 1997, due to the role that the academy plays, as the main generator of research in Costa Rica, during the Figueres-Olsen national presidency.
Because of that, In October 1997, the Government of the Republic presented to the Consejo Nacional de Rectores (CONARE) an initiative to use the formerly used building by the US United States Agency for International Development (USAID) for the establishment of a national center in high technology, through which the academia would be linked with the Government and the productive sector, in areas of high impact linked to the attraction of foreign investment, for the benefit of national development. The proposal used Korea, Singapore, and Israel -the latter with the Technion or Israeli Technological Institute, located in Haifa- as reference countries.




On May 25, 1998, the Legislative Assembly enacted Law 7806, authorizing the transfer of the building to CONARE to create the Centro Nacional de Alta Tecnología (CeNAT) and call it after Dr. Franklin Chang Díaz. Furthermore, Article 3 of that law would also provided for the creation of the Centro de Alta Tecnología Foundation (FunCeNAT), whose purpose is to fulfill the legal duty of managing the resources required for the execution of the projects developed through CeNAT.



6
Subsequently, the CONARE, under the Coordination Agreement for State Higher Education, in session number 5-99, on March 2, 1999, created the CeNAT.


Under the above the above, CONARE supported the proposal to create a scientific and technological development center, which would enhance the research efforts of universities.
This is how CeNAT was formed as an inter-university encountering instance for the academy, the Government, and the productive sectors of the country, in different high technology fields, thus joining forces to enhance the potential of the country and to take advantage of the opportunities that technological development offers to countries that, like Costa Rica, have invested significantly in the education of their population at all levels.
During these years, the Center has consolidated a work platform based on the high technical-professional capacity of the personnel in its areas and laboratories, its equipment, and facilities, thus allowing it to promote various research and knowledge transfer projects, focused on the vision to transform knowledge into development.
7
Strategic Planning


The year 2023 was an important year in terms of Strategic Planning. This year, CeNAT had an updated philosophical framework of its Strategic Plan and the Strategic Plans of its laboratories, including a mission, vision, and development goal that guide the course of the institution during this five-year period. However, this philosophical framework had to be updated to address new realities.


















8


For this reason, during the year 2023, the new Strategic Plans of CeNAT and its laboratories were worked on for the 2024-2028 five-year period. It involved a process of permanent consultation and teamwork that allowed each of the laboratories to set the philosophical framework of CeNAT strategic plan, namely CENIBiot, LANOTEC, CNCA, PRIAS and the Environmental Management area. Based on the PLANES guidelines, the issues of regionalization and SDGs were assessed in the diagnosis.


The conclusion of the process determined that each laboratory has a different nature of undertaking its substantive management; therefore, the consultancy was asked to delve into the following aspects:
Diagnosis of the organizational perception of CeNAT.
Guidelines to address organizational lines of each Laboratory.
Review the philosophical framework of the 2019-2023 Strategic Plan.
Plan the substantive actions of each laboratory.
Achieve an index that identifies the indicators of the substantive activity of each instance.
Achieve an index that specifies the financing monitoring indicators.
Integrate each of the philosophical frameworks to the areas of each laboratory into the CeNAT Strategic Plan.
Each of the points stated was worked on in a participatory manner with the management of the area and laboratories, integrating leading professionals and key informants into the discussions who validated the progress of each aspect expressed.
9

CENTRO NACIONAL DE ALTA TECNOLOGÍA
Transforming knowledge into development

Mission of CeNAT
“We are an inter-university coordination body that facilitates and promotes the proper functioning and systemic development of scientific research in higher education, in various areas of high scientific-technological content, oriented to research, linkage, environmental development, and extension, within an innovation framework with the government, civil society, and the private sector” (as inspired by the constitutive deed of CeNAT).
Vision of CeNAT
"To be a leading innovative Center that generates high-technology knowledge, products and services for the promotion of high-impact scientific-technological collaboration, promoting learning spaces, strengthening competitive development, and knowledge exchange at the highest level, while enhancing the mechanisms that support inter-university and institutional coordination of excellence both at national and international levels".
In addition to its mission and vision statements, CeNAT incorporated a Development Goal into its philosophical framework, as a contribution by the Center to the development of the country.
Development Goal
To conduct research activities that will provide the country with the necessary, relevant, and strategic technology for competitive development of the different sectors of society, in the economic, social and environmental scopes, through innovation, development, training and services in science and technology (based on the constitutive deed of CENAT).
10
Main Objective
To conduct training and research activities that would provide the country with the necessary, relevant, and strategic technology for the competitive development of the different sectors of society in the economic, social, and environmental areas.

Objectives of CeNAT
The objectives come from the constitutive deed of CeNAT, which guides institutional work, contribution, and the areas that it should manage to address the impact of the scientific exercise.

Specific Objectives
The specific objectives describe the major categories that come from the constitutive deed towards their orientation to collaborate to the scientific development of the country.
11





Regarding Science Promotion
To promote the development of research activities to provide the country with the necessary, relevant, and strategic technology, for the competitive development of the different sectors of society in the economic, social, and environmental areas.
To carry out anything that represents social, cultural, and scientific wellbeing according to or pursuant to Article 1 of the Law on Foundations.
Regarding Information and Training
To promote the creation and to provide contributions to support thinking spaces, as well as to coordinate actions that support scientific and technological development and conformation of multidisciplinary teams of researchers with a high level of training and experience (high level of critical mass), especially at the graduate level.
To promote technology extension, through exhibitions, conferences, seminars, technology markets, and training courses, among others.

12

Regarding Contribution to Postgraduate Specializations
To promote and support the implementation of academic research programs at the graduate level in coordination with state higher education university institutions.
Regarding Contribution to the Country's Development
Regarding Inter-Sectoral Linkage

To promote the coordination of public and private sectors involved in generation, training, transfer, and application of high technology.
To encourage and promote the generation of businesses with high technological content and high added value for the country.
To conduct -with research purposesactivities for development, licensing, utilization of resources (know-how), donation or purchase of patents, inventions, industrial or utility models.

To publicize and sell publications arising from research; to assign, sell, transfer, and grant licenses for use of its patents, industrial or utility models, as well as any other assets that belong to its intellectual property.



















































13
Values and Principles Enforced at CeNAT


Our values comprise those indicated by CONARE, and then the values and principles that are enforced at CeNAT are presented below.







Institutional
of Communication Planning Quality Transparency CONARE 14
Values
Willingness to excellence in the work that is undertaken
Transparency in the exercise of research
Tolerance and flexibility in the processes that are developed
Ongoing learning attitude
Critical and self-critical position to address improvements in all research processes
Continuous personal improvement attitude at the scientific level


Collaborative and integrated work in all processes
Scientific rigor in the studies undertaken
Work conducted within interdisciplinary complexity
Effective communication

Accountability in goals and times set for each task
Commitment to impact generation on the actions undertaken

Principles Enforced at CeNAT CeNAT 15
Values Enforced at



CeNAT Strategic Areas
Materials Science and Engineering
Biotechnology

The strategic lines are present in the substantive work of CeNAT. They are defined as areas of strategic development of each Laboratory and the Environmental Management Area.

Advanced Computing
Environmental Management
LANOTEC CENIBiot CNCA PRIAS Agromatics Climate Change
Life Sciences
Standards and Regulations
Scientific Vocations
Sustainable agriculture
Microbial communications
Bioprocesses
Drug discovery

Artificial Intelligence
Bioinformatics
High Performance Computing
Scientific Computing
Data Science
Advanced Networks
Infrastructure
Geospatial Management
Geoinformatic Development
Aerospace Catalyst
Variability and Climate Change
Agromatics
Clean energies

These strategic lines highlight the importance of the collegiate work of each dependency that makes up the organization, where each action contributes to efficiency and projection.
16
Strategic Lines
CeNAT
The strategic lines are present in the work of CeNAT. They are defined as cross-sectional lines of the substantive activities carried out by the laboratories and the Environmental Management Area.
These strategic lines highlight the importance of the collegiate work of each dependency that makes up the organization, where each action contributes to efficiency and projection.

The strategic lines and their definitions are identified below.
Knowledge Generation:
It provides the country with knowledge on relevant and strategic high technology, for the competitive development of the different sectors of society in the economic, social, and environmental scopes.
Learning Transfer:
It supports learning spaces from interuniversity coordination to articulate actions that support scientific and technological development and the formation of multidisciplinary groups of researchers with high scientific rigor.
Internationalization:
It strengthens knowledge exchange at the highest national and international levels, both in the public and private sectors.
Institutional Management:
It strengthens organizational management through mechanisms that support the sustainability of CeNAT promoting efficient and transparent accountability and the development of scientific relevance.
17






Our Areas, Laboratories, and Programs







Areas
Materials Science and Engineering
Biotechnology
Advanced Computing
Manufacture
Environmental Management
Science, Culture and Society
Laboratories
National Nanotechnology Laboratory (LANOTEC)
CENIBIOT Laboratory
National Collaboratory of Advanced Computing (CNCA)
PRIAS Laboratory
Programas
Climate Observatory
Agromatics
CREATEC
CeNAT - CONARE Scholarships
CeNAT Teaching
19

Biotechnology Area:
II. Advanced Computing Area:
Since 2013, the CENBiot Laboratory integrates this operational area.
IV.
III. Manufacturing Area: There is no operating unit attached to it.
Since 2009, the National Advanced Computing Collaboratory (CNCA) is part of it.
and CeNAT-CONARE Scholarship programs.
VI. PRIAS Laboratory: It started in 2003.
Environmental Management Area (AGA): This area includes one laboratory and two programs:
Programas:
Variability and Climate Change
Observatory: It started in 2010.
Agromatics, Food Safety, and Slow Food: It started in 2010.
20
13 years Variability and Climate Change Observatory
Agromatics, Food Safety and Slow Food
10 years
CENIBiot Laboratory
19 years National Nanotechnology Laboratory (LANOTEC)
14 years Advanced Computing Collaboratory (CNCA)

20 years PRIAS Laboratory
1998 (25 years)




CeNAT 2023
2013 2010 2009 2004 2003 21






Organizational
Materials Science and Engineering Area Biotechnology Advanced Computing Environmental Management Infrastructure LANOTEC CENIBiot CNCA PRIAS ÁREA DE GESTIÓN AMBIENTAL Life sciences Microbial communities Bioprocesses Metabolic diseases Sustainable agriculture High Performance Computing Scientific Computing Advanced Networks Data Science Bioinformatics Artificial Intelligence Catalyst Aerospace Technology Clean energies Agromatics Variability and Climate Change CeNAT Teaching CREATEC Cenat - CONARE Scholarships Geo-computer development Geospatial Management Programs Programs Standards and Regulations Scientific Vocations Monitoring of the organizational management indicators of the laboratories and the Environmental Management Area Monitoring of the organizational sustainability indicators of the laboratories and the Environmental Management Area Science, Culture and Society Director General of CeNAT
NACIONAL DE RECTORES Scientific Council composed of CONARE Vice-Chancellors for Research FunCeNAT does not belong to the CeNAT structure, its role is to provide services and support in administrative, financial, and legal management. FunCeNAT Executive Management Board of Directors FunCeNAT Administrative Management Services Financial Management Services Legal Management Services Human Talent Management Services Communication Management Services Strategic Consulting and Management International Articulation High Technology Equipment Strategic Scientific Communication 22
Development of CeNAT
CONSEJO








The managing actions of CeNAT's Directorate are aligned to what was defined in the constitution deed of the Centro Nacional de Alta Tecnología, as follows: It seeks the correct performance of CeNAT, following the guidelines dictated by CONARE and the strategic lines defined by the Scientific Council.


The fundamental basis of the work of the Directorate is to watch over the strategic lines of the Center, such as:

Monitoring and execution of agreements and conventions of CeNAT
Establishment of the operational tactics and goals to be developed by the organization
Overseeing the Sciences, Culture, and Society areas, which integrate the following programs:







Continuous follow-up to the actions carried out by each area and program attached to CeNAT CENAT Teaching CeNAT-CONARE Scholarships

23






CeNAT Results






For CeNAT, the year 2023, in terms of technical achievements, was a very productive year in publications, research and knowledge transfers, among others. All of them allow us to contribute to the development of society.



FULFILLMENT l SEMESTER ll SEMESTER TOTAL Number of publications Number of knowledge transfers carried out Number of projects executed on time Completed Agreements Support to students in academic development projects Percentage of essential and operational actions 58 139 64 12 156 443 8 18 31 2 21 181 66 157 95 14 177 624 24
INDICATORS
Teaching
CeNAT Teaching is part of Science, Culture and Society, one of the areas of CeNAT.
In this program, knowledge transfer activities are visualized. With this goal, CeNAT Teaching organizes lectures, workshops, and conferences aimed at different sectors of society, government, and academia, taught by world-class national and international experts, and linked to activities and/or projects of CeNAT, in scientific and technological subjects. In 2023, CeNAT Teaching was not operational.
25
Relevant Lectures: LANOTEC
In 2023 there was participation in relevant lectures, which are listed below:

Modulation, analysis, and application of surface chemistry: a collection of stories
This lecture took place in person at the Department of Materials Science of the National Yang Ming. The event was organized by Prof. Hsin-Chieh Lin. It was taught by researcher Sergio Paniagua on January 20, 2023.
The Scientific Collaboration of LANOTEC in the Area of Polymers and Bioplastics
Lecture: CINDE international webinar: Bioprocessing, Microalgae and Biopackaging/Bioplastics. The event was held virtually and was organized by CINDE. The exhibition was developed by researcher Diego Batista on February 28, 2023.
Biotechnology: engine for social and economic development in Costa Rica
Participation at the CRBiomed event: Biotechnology and Life Sciences Cluster. The Event was held virtually and was organized by CRBiomed. The conference was imparted by the director of LANOTEC, José Vega on June 9, 2023.
Nanotechnology and 3D printing applications
On August 29, 2023, the “Science Fair for Children” event was held in person. The event was organized by the CONARE Research Promotion subcommittee. The speaker from LANOTEC was researcher Rebeca Corrales.

26


Sphingolipid-based synergistic interactions to enhance chemosensitivity in lung cancer cells
A lecture imparted by researcher Susana Mesé during the international event, “Sphingolipid Biology: the dawn of a new era” in Portugal. The event was organized by FEBS.
Nanoformulations of natural products: curcuminoids from Curcuma longa and proanthocyanidins from Uncraria tomentosa

The Chemical Society of Peru and SILAE organized the XXX Peruvian Congress of Chemistry and XXX Italo-Latin American Congress of Ethnomedicine, where on October 18, 2023, researcher Andrea Araya taught, in person, the lecture “Nanoformulations of natural products: curcuminoids of Curcuma longa and proanthocyanidins from Uncraria tomentosa”.
Generation and Applications of Aluminum-Based Nanostructures: from Antibacterial Surfaces to Plasmonic Substrates
El 20 de octubre el investigador Sergio Paniagua impartió la charla citada anteriormente, durante la Conferencia del Caribe sobre Materiales Funcionales CARIBMAT 2023, en Puerto Rico. El evento fue presencial.
27




CNCA
Evaluation of Alternatives to Accelerate Scientific Numerical Calculations on Graphics Processing Units using Python, by researcher Johansell Villalobos, at the “CARLA 2023 Latin America High Performance Computing Conference” event.
Benchmarking AI-based plasmid annotation tools for antibiotic resistance genes mining from metagenome of the Virilla River, Costa Rica, by researchers Melany Calderón, Dorian Rojas Villalta, Kenia Barrantes, María Arias, and Keilor Rojas, at the “5th IEEE International Conference on “BioInspired Processing, BIP 2023”.


Microvilli Semantic Segmentation in Microscopy Images Using a Visual Learning Pipeline, by researcher Fabricio Quirós, at the 22nd IEEE International Conference on Machine Learning and Applications, ICMLA 2023.


28

Speaker: Randall Loaiza Montoya
CENIBiot
Max Chavarría Vargas
Symposium: I Costa Rican Symposium on Environmental Microbiology: from Biodiversity to Biotechnology, San José,
Date: Monday, October 23, 2023
Lecture at Digital Sequence Information (DSI) collaborations for biodiscovery", during the scientific sessions held during the United Nations General Assembly (UNGA78)
Modality: Virtual
Date: September 18, 2023
Speaker: Emanuel Araya Valverde
Lecture: Latest research on the diversity of the tropical palm Acrocomia aculeata in Costa Rica and its potential for oil production, University of Göttingen, Germany
Modality: Virtual
Date: Saturday, February 25, 2023
29

ENVIRONMENTAL MANAGEMENT

Sustainable purchasing practices within the institution and our homes, conducted by researcher Jazmín Calderón Quirós on November 20, 2023. CONARE, via Zoom
Primatology Symposium XI: Seed dispersal by (Alouatta palliatta) in severely disturbed habitats, Santa Cruz, Guanacaste, Costa Rica, conducted by researcher Jazmín Calderón Quirós on November 22, 2023. Panama, via Zoom
Wastewater workshop: "An impact on the environment", conducted by researcher Jazmín Calderón Quirós on November 28, 2023. CeNAT/CONARE, via Zoom
Workshop - Actions within the institution to address climate threats, conducted by researcher Jazmín Calderón Quirós on November 29, 2023. CONARE
Refrigerant gas lecture “A simple action for a big impact”, conducted by researcher Jazmín Calderón Quirós on November 29, 2023. CeNAT/CONARE, via Zoom
Lecture: “An opening to solid waste management”, conducted by researcher Jazmín Calderón Quirós on December 11, 2023. CONARE
Expression and gastronomy workshop “The pejibaye in your hands”, conducted by the coordinator of the Agromatics, Food Security and Slow Food program, Patricia Sánchez, June 17, 2023. Museo Nacional.


30
PRIAS
Environmental-geospatial learning experiences within the framework of action of the PRIAS Laboratory and geospatial information at the service of citizens. Researcher Heileen Aguilar and infrastructure analyst Stephanie Leitón presented the topic, Environmental-geospatial learning experiences within the framework of action of the PRIAS Laboratory at the Virtual Symposium on Environmental Education Experiences, held on September 28, 2023
Master lecture about the work of the PRIAS laboratory: PRIAS, 20 years building geospatial research. November 27, 2023, at the PRIAS 20 years of Geospatial Research event. As part of this, the director, Cornelia Miller, gave a master lecture about the work of the laboratory and the researcher Heileen Aguilar gave the closing words about the commitments and upcoming goals that PRIAS will be carrying out
Lecture about the MONEO-WET project. May 2, 2023. Researcher Iván Ávila gave a keynote talk to students from the School of Environmental Engineering of the Technological Institute of Costa Rica about the MONEO-WET project in the segment "Talks at noon" organized by the school. He was accompanied by researcher Heileen Aguilar and there the CeNAT-CONARE Scholarship program was also promoted
PRIAS, 20 years building geospatial research: In December 2023, director Cornelia Miller participated as a guest at the first Latin Women in Space session with a presentation on PRIAS' 20 years of building geospatial research and her role as a female leader in STEM areas with a focus on earth observations.


31
CeNAT –CONARE Scholarship Program

On the initiative of the Deans of CONARE's member universities, in 2013, the scholarship program started, which is aimed to encourage students enrolled in the state universities to develop final graduation or research works, linked to the areas of CeNAT.
The goals and topics related to these research works and theses should be directly linked to the competence topics of LANOTEC CNCA, CENBiot, PRIAS, and Environmental Management, according to specific contests that are held at public universities, which are disseminated by the institutional media and by the Vice-Chancellorships for Research at each university.
During the year 2023, upon request from the State Distance University (UNED), the dates of the contest were adjusted so that adjust to their own school cycles, so that the 2023 scholarship contest began on November 28, 2022 and was extended until August 2023, so that they began in September 2023 and are projected to conclude in June 2024.
An important milestone was the celebration of the first 10 years of the CeNAT/CONARE Scholarship Program, within the framework of which the first report of the scholarships developed during the last 10 years. In addition, a poster presentation of the 2022-23 scholarships and a high-level protocol event were held on August 22, 2023.

With the intention of avoiding overlapping scholarships and adjusting calendars, the 2024-25 contest began on December 10, 2023 to conclude the entire process in June 2024 and with the expectation of starting the new scholarships in July 2024.
For the scholarship promotion strategy, five different promotional posters were produced, according to affinity with the different laboratories, and the four promotional videos developed the previous year were reused. The posters are displayed below.












Allocated

UCR UNA UNED ITCR UTN TOTAL / LAB UNIVERSITY
CENAT - CONARE 2018-2023 SCHOLARSHIPS NUMBER - UNIVERSITY - LABORATORY LANOTEC CENIBIOT ENVIRONMENTAL MANAGEMENT CNCA PRIAS TOTAL / UNIVERSITY 3 2 0 1 0 6 1 0 0 2 0 3 2018 5 1 0 2 0 8 2019 7 0 1 1 0 9 2020 1 0 0 3 0 4 5 0 0 1 0 6 2018 2 1 0 0 0 3 2019 2 0 0 2 0 4 2020 1 1 0 0 0 2 1 1 2 0 0 4 2018 0 0 1 1 0 2 2019 1 0 1 0 0 2 2020 5 1 0 1 0 7 4 0 0 0 0 4 2018 4 0 0 1 0 5 2019 2 1 0 0 0 3 2020 6 0 0 1 0 7 2021 2022 2 1 0 0 0 3 2021 2022 2 0 0 0 0 2 2021 2022 2 0 0 1 0 3 2021 2022 0 2 0 1 0 3 1 1 1 2 0 5 2018 0 0 0 1 0 1 2019 2 0 0 3 0 5 2020 3 1 0 2 0 6 2021 2022
Source: Information on the year 2023 provided by the Laboratories and Area of CeNAT.
TABLE 1
10 6 0 6 0 22 12 2 3 5 0 22 2018 11 2 1 5 0 19 2019 14 1 2 6 0 23 2020 2021 15 2 0 4 0 21 2022 2023 5 1 1 0 0 7 3 2 0 1 0 6 2023 2 0 0 1 0 3 2023 2 0 0 2 0 4 2023 1 0 1 0 0 2 2023 Subtotal Subtotal Subtotal Subtotal Subtotal 2023
number of CeNAT-CONARE scholarships 2018 to 2023 by laboratory and area LANOTEC CENIBiot Environmental Management CNCA PRIAS 27 4 2 7 0 40 20 5 0 3 0 28 7 2 4 3 0 16 14 1 0 8 0 23 7 4 2 9 0 22 13 3 2 4 0 22 40 28 16 23 22
Scholarships (by university and laboratory per year) from 2018 to 2023
Total
TABLE 2
Detail of the Scholarships allocated in the year 2023


Source: Information on the year 2023 provided by the Laboratories and Area of CeNAT. DETAIL OF ALLOCATED SCHOLARSHIPS
Adolfo Enrique Piedra Mora
Brayan Rodriguez Delgado
David José Araya Gutiérrez
Dilan Rojas Saborío
Dorian Rojas-Villalta
Esteban Bertsch Aguilar
Development of a parametric three-dimensional model of the historical architectural heritage of the Hermitage of Agony of Liberia with HBIM methodology using three-dimensional laser scanning
Implementation of an automated learning algorithm for the detection of burned areas with satellite images in Costa Rica
Genetic diversity of the Hevea brasiliensis tree (Willd. Ex A. Juss) for commercial cultivation in Costa Rica
Collagen membranes reinforced with natural nanofibers obtained from biomass for guided tissue regeneration
Genomic and functional bioprospecting of new molecules with antibiotic potential in new strains of Extremophilic microorganisms from Antarctica
Creation and Evaluation of Computational Models for the Prediction of Lipophilicity in Carbohydrates


UCR UNA UNED TEC UTN TOTAL / LAB University
No. Student Proposal University Area/Laboratory 1 2 3 4 5 6
UCR UNED TEC UNA TEC UCR PRIAS PRIAS CENIBiot CENIBiot CNCA CNCA ALLOCATION OF SCHOLARSHIPS 2013 - 2023 CNCA 29 1 1 10 0 41 CENIBiot 30 17 0 12 0 59 LANOTEC 35 10 2 11 0 58 PRIAS 8 10 4 15 0 37 Total / University Environmental Management 8 6 5 4 0 23 110 44 12 52 0 218
Geisel Cabrera Lazo
Isaura Gutiérrez Vargas
Javier Stuardo Chinchilla Orrego

Johana Valera Rangel
Jordan Hernández Ledezma

Julián Sánchez Castro
Karen Andrea Salazar Barrantes
Encapsulation prototype of Trichoderma sp. with polymer matrices to combat Fusarium sp. in papaya cultivation
Machine Learning for the forecast of minimum flows on the Pacific slope of Costa Rica

Analysis of the process and quality of synthetic and artisanal compost (Takakura) obtained from the degradation of PLA (40 μm) used for food packaging
Characterization of metabolites with antifungal activity produced by actinomycetes of the genus Pseudonocardia

Laura Rojas Artavia
Lucía Noboa Jiménez
“Novo prosperous coffee: morpho-physiological and molecular performance of candidate M3 mutants of coffee (Coffea arabica L cv. Catuaí) in response to “orange rust” (Hemileia vastatrix) and the increase in temperature”
Simulation of the magnetic field of the stellarator SCR-1 for the calculation of the radial velocity and visualization of the field vector map in turbulent flow
Atorvastatin calcium trihydrate: solid state characterization, compatibility study and effect of the tablet production process on its polymorphic stability

UNA
UCR
UCR
CENIBiot
CNCA
LANOTEC
UCR
UNED TEC
CENIBiot
LANOTEC

Polylactic Acid Nanofiber Scaffold Impregnated with Deflazacort with Air Jet Spinning Technique
Ultrastructural changes and gene expression patterns induced by Trichoderma rifaii in Coffea
UCR
UCR
UCR
CNCA
LANOTEC
LANOTEC
CENIBiot

LANOTEC

No. Student Proposal University Area/Laboratory 7 8 9 10 11 12 13 14 15
DETAIL OF ALLOCATED SCHOLARSHIPS
Fiorella Calderón (Extensión)
DETAIL OF ALLOCATED SCHOLARSHIPS
Experimental determination of the significant variables of a granulation process in a fluidized bed equipment and a coating process in a perforated drum equipment of the Pharmaceutical Research Institute (INIFAR) for the manufacture of coated tablets
Diversity and genetic structure of the coral Pocillopora spp at two sites in the Eastern Tropical Pacific
Evaluation of Raman signal enhancement of rhodamine 6G on gold layers with commercial optical disk nanotopographies, by means of SERS spectroscopy
Dietary flexibility of howler monkeys (Alouatta palliata palliata) in altered habitats in Santa Cruz, Guanacaste: implications for sustainability and conservation
Development of a clean, photovoltaic, and wind powered system from peripherals (computers, refrigerators, compressors, and others) of a mobile laboratory, an electrical prototype, Mission Antarctica 2022 – 25
Design of a mobile research center
Prototype powered with clean energies for the scientific expedition to Antarctica in January 2022-2025.
UCR UCR
UCR
UCR
ENVIRONMENTAL MANAGEMENT
ENVIRONMENTAL MANAGEMENT
ENVIRONMENTAL MANAGEMENT


Summary
All the approved proposals have a high impact both in the generation of new knowledge (through articles, graduation papers, new product generation, and related), and in issues related to clean energy, new product generation, and prevention of natural disasters, throughout these 10 years.
Furthermore, the result quantitatively speaking demonstrates very good management and promising future projections, thanks to the Program's great capacity for adaptation and resilience.
No. Student Proposal University Area/Laboratory 17 18 19 20 21 22 Michael Solano Rojas Randall Vinicio Hidalgo Sánchez Sebastián Moya Salas Vanessa Morales Cerdas Andrea Rivera Álvarez (Extensión)
UCR TEC LANOTEC CENIBiot LANOTEC

LANOTEC



Public Private Total LANOTEC Annual Operational Plan (CeNAT-CONARE) 2023 DISTRIBUTION OF GOALS ACHIEVED INDICATOR Scientific publicationsDissemination 27 6 33 Knowledge transfer activities 33 7 40 Research projects 18 18 36 Attention to students Agreements 3 1 4 55 9 64 39
INTRODUCTION
The National Nanotechnology Laboratory (LANOTEC) is attached to the Centro Nacional de Alta Tecnología (CeNAT). On October 18, 2004, it started conducting research with the goal of being a technological leader in the Central American and the Caribbean region, with cutting-edge engineering on the study of advanced materials for research, design, and training in technologies associated with microtechnology, nanotechnology, and materials science.
It specializes in the study of materials, development of scientific research and generating knowledge from the various areas that work in synergy for the development of advances in science, allowing collaboration


It has established areas in which scientific research, innovation-entrepreneurship, as well as teaching and extension predominate.
development of technologies that allow improvement of products and processes in the industrial sector and help to reduce the gap in nanotechnology between developed and poor countries. This will be achieved with training and support of a scientific committee that, together with the Director, mark the course that Laboratory should follow in scientific research.
40
Development Goal
To generate scientific value from nanobiotechnology to process and product innovation initiatives that impact economic development of Costa Rica.

Mission

Vision
We are a research laboratory for the use of nanobiotechnology that has specialized professionals who carry out studies with the highest scientific standards within the framework of innovation and development for the public, private, and social sectors of the Region.
We aim to be a self-sustaining research laboratory with high economic impact both nationally and internationally, which contributes to knowledge generation in nanobiotechnology, being a leader in strengthening competitive development and intersectoral articulation.
41


Values
Collaborative management in the projects that are undertaken
Socialization of scientific information
Responsible project management
Commitment to the processes and products that are undertaken
Principles
Efficient use of time
Efficient use of technological infrastructure
Accountable administrative management of research projects
Generation of ideas for process improvements
Innovation and development
LANOTEC Strategic Development Areas Life sciences Standards and regulations Scientific Vocations 42
Strategic



Strategic Nodes

Innovation and entrepreneurship accreditation
Scientific research
Innovation and entrepreneurship
ISO 17025 accreditation
Scientific research
Outreach and Teaching
Art (Nanoart, conceptual art, and sports)
Outreach and Teaching
Art (Nanoart, conceptual art, and sports)
43

















Otherindexed
TOTAL 33 29 4 Indexed in Scopus Impact Q1 Q2 Q3 Q4 Specialized Indexed SCIMAGO Scopus Indexed in other indices Total 13 3 1 15 4 27 2 1-2 1 6 15 4 1 17 5 33
PUBLICATIONS
Classification Public Private Total Indicators 44
Detail of publications:





























































































TRANSFERS KNOWLEDGE TOTAL 40 35 National People benefited: Workshops Courses, symposia
International Workshops Courses, symposia 1,038 45
5

Projects TOTAL 36 18 Public FEES CONARE Funds Internal (OPERATIONAL LANOTEC) 2 3 13 TOTAL 64 Scholarships Thesis support – Final graduation project, Internship, and Volunteering Assistant hours 15 37 12 18 Private Other Public Funds Private funds 4 14 Attention to Students National Linkages International Linkages 9 3 Projects in negotiation Dos Pinos Coopeatenas 46
Research
Linkages




National Academic Sector:
University of Costa Rica
National University
Costa Rica Institute of Technology,
National Tecnical University
State University for Distance Education
Invenio University
ULACIT, ULatina Costa Rica
International Universities or Institutes:
University of the Republic of Uruguay
Private Northern University, Peru
Max Planck Institute, Germany
University of Belgrade, Serbia
University of Buenos Aires, Argentina
Sorbonne University, Paris, France
International companies:
Philips Morris
Confluent Medical
Boston Scientific
Allergan
Smith Interconnect
Proquinal
CooperVisión Establishment Lab
Ilsi Mesoamerica
National companies:
Stein Laboratories
Calox Laboratories
Lisan Laboratories
Florida Ice & Farm Corp.
Asoproa
Ecoinsumos
47





4
International 3 1 48
Agreements TOTAL
National




Project
Role of neutrophils and complement in the modulation of the immune response against bacterial infections of importance in Costa Rica
Obtaining biodegradable films with antimicrobial activity from agroindustrial and marine waste
CONARE-FUNDED PROJECTS
Project
LANOTEC Operation
Costa Rican Chemistry and Science Olympiad (OLCOQUIM)
Max Planck: Understanding of the velvet worm anti-adhesive sin mechanism as a model for biodegradable and low protein adsorption coatings
Summary of Projects


General description
This project allows generating basic scientific information on the pathogenesis and biology of these bacteria. It favors interuniversity collaboration and the training of new researchers and improves the general understanding of two bacterial infections of high importance in animal and human public health at the national level
The objective of this proposal is to develop biodegradable chitosan films, with antimicrobial activity, from agroindustrial and marine waste
General description
Promotion of scientific development in the Region through collaborative work between the LANOTEC team of researchers and students, focusing on the execution of projects, the publication of results, the creation of agreements and the transfer of knowledge. The purpose is to generate a significant impact in the public, private and social sectors, contributing to the advancement and strengthening of the region
The purpose of this project is to promote scientific vocations and environmental management in students who participate in the Costa Rican Science and Chemistry Olympiad, within the general framework of the ODES
This project aims to generate fundamental knowledge about the non-stick properties of velvetworm skin and its mechanisms to design sustainable non-stick coatings, within the concept of biomimicry
1
1 2 3 2 FEES PROJECTS
49

General description Project
CSIC- Arsenic-free - new nano-structured multifunctional materials to remove arsenic in groundwater


ARSENIC-FREE proposes to contribute to human development through the implementation of international collaborative development with a scientific-technological basis. The development consists of the manufacturing, characterization and scaling of a membrane composed of electrospun nanofibers containing nanoparticles with high As uptake power. Due to the adsorption mechanism and its low cost, the membrane does not require electrical energy to act and therefore can be used both in developed urban centers and in vulnerable communities without access to electrical energy or safe water

Structural elucidation of Irbesartan Form A using Rietveld and Le Bail methods
Development and implementation of tools for understanding nanotechnology from practice: making the invisible visible 2021-2023


Work is being done in collaboration with the Applied Crystallography Laboratory of the General San Martin University of Argentina. Experimental powder X-ray diffraction data of Irbesartan form A have been used. Rietveld and Le Bail methods have been applied to these data using the FullProf Suite software. Not very promising results have been obtained so far; therefore, work is being done on the manually determined calculations of all the hkl reflections of the structure, based on the record of this structure reported in PDF4/Organics
The objective is to train educators and adolescents in bionanotechnology through lectures and practices using easy-to-understand language. Costa Rica-Uruguay Bilateral Project. The scheduled workshops on the dissemination of nanotechnology were held, both in Costa Rica and Uruguay


Additionally, the respective recordings were made for the editing of the videos related to the experimental part related to nanobiotechnology


1 2 3
OPERATIONAL PROJECTS (INTERNAL PROJECTS)
LANOTEC
50

Project
Crystal polymorphism in nanomaterials and soft systems: basic aspects and technological relevance
General Description
This is a macro project that addresses several topics, LANOTEC specifically participates in the line “Polymorphism in compounds of pharmaceutical interest: influence of crystallite size” , whose objective is to study the influence of crystallite size on the retention of the most suitable polymorphs of the selected molecules (saquinavir and curcumin) for their bioavailability. Crystal size reduction processes will be considered with equipment available in the pharmaceutical industry. Accordingly, the results obtained can be extended to other molecules of pharmacological interest
Identification of the proteins of the vascular basement membrane and surrounding extracellular matrix to which snake venom metalloproteinases bind by means of immunoelectron microscopy studies
Development of a prototype of a medical device that allows the minimally invasive approach to neurological pathologies
Effect of the tablet production process on the polymorphic stability of atorvastin calcium trihydrate
To study the distribution and colocalization of different types of hemorrhagic metalloproteinases from snake venoms with proteins of the vascular basement membrane and surrounding extracellular matrix in murine muscle tissue by means of immunoelectron microscopy tests in order to identify the component to which these toxins bind
The objective of this project is to develop minimally invasive access mechanisms and artifacts that facilitate the development of complex neurological operations, using 3D printing from the LANOTEC FabLab, in conjunction with Dr. Miguel Esquivel from Hospital México
Characterization of the raw material of atorvastatin calcium trihydrate (ATC) and evaluate the impact of manufacturing processes on its polymorphic stability, including the analysis of drug-excipient interactions as an integral part of preformulation studies. The purpose is to guarantee the quality and safety of the final product by understanding and controlling the polymorphic aspects during the formulation of the ATC, thus contributing to the optimization of its manufacturing process
Development of nanoparticle carriers of natural polyphenols to control grain contamination by mycotoxins.
Development and evaluation of the effectiveness of polymeric nanoparticles (NPs) that encapsulate polyphenols extracted from Costa Rican plants, in order to control mycotoxins in grains such as corn, beans, rice and peanuts. This project also aims to provide a viable alternative for small producers by addressing the limited stability and solubility of polyphenols, and at the same time, guarantee the safety of grains stored in common conditions used by these producers in Costa Rica
4 5 6 8 7
OPERATIONAL PROJECTS (INTERNAL PROJECTS) 51
LANOTEC

LANOTEC OPERATIONAL PROJECTS (INTERNAL PROJECTS)
Interaction of metal oxide nanoparticles of relevance in soils with phosphate ions and organic matter


Evaluation of the potential of fluorescent sensors analogous to sphingomyelin to identify mechanisms of chemotherapeutic interactions in cancer cells

Safety, sustainability and resilience in domestic and small-scale biogas utilization systems in the agricultural and agroindustrial sector
Comparison of the reactivity of three iron and aluminum oxide mineral nanoparticles (ferrihydrite, nano-Al(OH)3 and allophane) in relation to phosphate and soil organic matter (SOM) retention. Use adsorption experiments on model systems and electron microscopy and spectroscopy techniques to characterize interactions at the micro and nanoscopic level. The purpose is to generate fundamental knowledge to understand the reactivity of NPox in soils, establishing the bases for future research on their impact on essential ecosystem functions, such as nutrient supply and organic carbon storage, in Costa Rican soils


To analyze sphingolipid metabolism and chemotherapeutic interactions in a lung cancer model using the A549 cell line loaded with a fluorescent sphingolipid analog (SM-BODIPY). We aim to investigate the cytotoxic interactions between conventional chemotherapeutic drugs (epirrubicin, cisplatin and paclitaxel) and perturbations in the sphingolipid pathway (enzymatic inhibitors) or autophagy modulators (activators or inhibitors) using fluorescence microscopy. The ultimate goal is to improve the understanding of cellular responses to treatments, with potential implications for the development of more effective therapeutic strategies against lung cancer

Development of a comprehensive project to modernize anaerobic biodigestion systems in Costa Rica, with emphasis on improving safety and efficiency in biogas production. The aim is to analyze and mitigate the associated risks, applying Materials Science for the purification of methane and the use of nanostructured materials such as activated carbon, graphene oxide and clay soils with iron oxides. LANOTEC will contribute with its experience in biorefining and development of nanotechnology for filters. The final objective is to implement a pilot plan in the Caribbean region, training beneficiaries in the safe and sustainable management of biogas and installing filters to improve the safety and efficiency of biodigestion systems


9 11 10
Project
General Description
52
Manufacture of biosolar cells from microalgae biomass: Double harvest of solar energy for production of photosynthetic proteins and photovoltaic energy
Microfluidic biosensor for detection of Brucella abortus: proof of concept for detection of infectious agents under WHO standards
Development of biosolar cells based on renewable biomass and photosynthetic organisms for efficient solar energy capture. Use nanotechnology to improve efficiency and overcome limitations in charge transfer in the electrodes. Implement a microalgae culture in the TEC under specific natural conditions to produce proteins and extraction of essential pigments for the construction of biosolar cells. Advance knowledge in Costa Rica to take advantage of these biological resources and apply them in devices with high added value, thus contributing to the development of more sustainable and efficient technologies in the capture of solar energy
Improvement of an existing microfluidic device into an affinity biosensor that allows specific detection of bacteria in biological fluids within 30 minutes. Introduce DNA aptamers to ensure specificity of detection. To evaluate the efficiency of the device to separate and concentrate bacteria in

12 13 BAC Credit Cards Project (BAC Cards) Evaluation of samples of credit and/or debit cards issued by BAC company made up of 2 commercial polymers 1 2 General Description Project Objectives Project LANOTEC OPERATIONAL PROJECTS (INTERNAL PROJECTS) 53
Promotion of scientific vocations Challenge Fair (Challenge ISEF)

H2020– Automated functional screening of IgGs for diagnostics of neurodegenerative diseases (AUTOIgG)
To encourage a rapprochement with the country's academic centers and provide support in the development of scientific events (fairs), in order to encourage the development of scientific vocations at the country level. This project depends on the interest of the organizers of the Scientific and Technology Fairs, as well as the national Engineering Fairs
It involves the development of experimental cellular models and procedures with immunoglobulins (IgGs) from patient sera as diagnostic and prognostic technologies related to neurodegenerative diseases, ND (particularly based on amyotrophic lateral sclerosis - ALS research). Additionally, the definition of the labeling characteristics of the standardized in vitro approach for ND diagnostic protocols, and the design of a small-scale platform based on automated fluorescence microscopy
Evaluation of PLA for the eco-sustainable manufacturing of packaging. (FIFCO)
Evaluation of the impact of cigarette smoke vs THS on indoor air quality. (PMI Air Quality)
Evaluation of the physicochemical characteristics of abaca produced in the Horquetas de Sarapiquí area and the development of a purification methodology for the fibers obtained by the Costa Rican extraction process. Abaca fiber project. (Nippon Paper)
Design and development of a concept model to establish a bioinformatic study of lung cancer by means of computer vision at nanomolecular-scale 3D images and circulating molecular biomarkers of associated genes (Lung cancer)
Evaluation of the antimicrobial activity of vinyl fabrics produced by the Proquinal company, Argento project, Phase II.
Research of alternative materials to plastic and composting processes to reduce environmental impact
The impact on air quality in an outdoor space, produced by the smoke emitted when smoking conventional cigarettes versus the aerosol generated by the THS device, was evaluated
The main objective of the project is to evaluate the morphological characteristics and silica content present in Abacá from Costa Rica. Additionally, compare with the data reported for crops from the Philippines and Ecuador and determine if the silica content is higher than that reported in other countries; to identify if there is a significant variation that may justify a partial removal process. It is proposed to study the structure of the internal and external plant, both mature and green, to understand their morphological and physicochemical differences
Design and development of a concept model to establish a bioinformatic study of lung cancer by means of computer vision at nanomolecular-scale 3D images and circulating molecular biomarkers of associated genes. This approach seeks to improve the understanding and analysis of the disease, allowing a detailed evaluation of nanomorphology and the presence of circulating molecular biomarkers for better characterization and diagnosis of lung cancer
The main objective of this project is to evaluate the antimicrobial characteristics of vinyl fabrics in terms of bacterial adhesion and antimicrobial activity of two types of fabrics LACA PH and LACA Spectra. For this, the morphology and roughness will be evaluated using AFM and SEM. In addition, microbiological tests will be carried out using two bacteria, a Gram - and Gram + bacteria, following the JIS Z 2801 test method.44. The protocols used in phase I will be followed
3 4 5 6 7 8 9 PRIVATE FUNDS PROJECTS
54
General Description Project
General Description Project
Development of a sensor system for the rapid determination of biomolecules. (Panama Project)
Biopolymer prototype, obtained from pineapple biomass waste. (BIO TAG)
Metal nanoparticles biosynthesized from agroindustrial waste applied in the functionalization of bioplastics for use in the berry industrial chain
Alternatives for interface-modified and 2D/3D perovskite absorbers for perovskite solar cell applications. (NAVAL)
Development of a sensor system with the purpose of achieving the rapid determination of biomolecules
Creation of a prototype of biopolymers using biomass waste from the pineapple industry
Development of metal nanoparticles through biological synthesis using agro-industrial waste and apply them in the functionalization of bioplastics intended for use in the berry industrial chain
Development and optimization of perovskite solar cells through the synthesis, characterization, and application of 3D-2D mixed perovskites. Design, synthesize and evaluate germanium-coordinated substituted arylamines as hole transporters (HTL) in these solar cells. Investigate the impact of using phosphonic acids and carbon quantum dots as surface modifiers and interfacial layers on the performance and stability of perovskite solar cells, by correlating them with properties such as surface energy, changes in local work function, morphology of the active layer, crystallinity and absorbance, using techniques such as force microscopy with a Kelvin probe
Biomaterials Prototype Development Program 2023 (CINDE – INA)
To provide the necessary technical support to small companies to promote the development of 10 product prototypes

10 11 12 13 14 PRIVATE FUNDS PROJECTS
55


Project
FI-55B-19: Revaluation of coffee brush as an alternative adsorbent material to activated carbon in the removal of bromacil from water sources
CB-0006-20: Nano-phytopharmaceuticals for the prevention and treatment of COVID-19: Scaling of solid-lipid nanosystems and in-silico and in-vitro studies of inhibitor candidates of the SARS-CoV-2 virus


General Description
Obtaining new low-cost adsorbent materials from coffee biomass as an alternative to activated carbon in the removal of bromacil from water sources
This project involves scaling the solid-lipid nano-formulation processes of curcumin and piperine and their complex materials for their application to other molecules of natural origin with structural similarity, elucidated from in silico and in vitro studies of inhibition of the SARS virus. -CoV-2 and treatment of COVID-19

PINN Cheesemakers: Generation of agro-industrial capacities and creation of a comprehensive unit (physical-chemical, organoleptic, and microbiological characterization) to improve the production process of Turrialba cheese with Designation of Origin
FI-0002-2022 Cancer therapy through micellar release of drugs based on Costa Rican natural products

It involves the generation of agro-industrial capacities and creation of a comprehensive unit (a physical-chemical, organoleptic, and microbiological characterization laboratoty- to improve the production process of Turrialba cheese with Designation of Origin
Development of smart micelles for the release of substances extracted from Costa Rican flora with potential in the treatment of cancer

OTHER PUBLIC FUNDS 1 2 3 4
56

CENIBiot










Private Total 1 15 2 30 5 26 1 2 7 72 CENIBiot Annual Operating Plan (CeNAT-CONARE) 2023 DISTRIBUTION OF GOALS INDICATORS 58
INTRODUCTION
The National Center for Biotechnological Innovations (CENIBiot) is an interuniversity Laboratory for research, development, innovation, and scaling up in biotechnology, attached to Centro Nacional de Alta Tecnología (CeNAT), with the financial support and oversight by the Consejo Nacional de Rectores (CONARE).
CENBiot contributes to the generation of innovative biotechnological solutions and strategic partnerships between the academic, business, and government sectors, through support for entrepreneurship, technology transfer and university-business linkage. This way it seeks to achieve its vision of being a "world-class interuniversity center in biotechnological innovation".
Its Development Goal is to generate biotechnological research that contributes to the development of Costa Rica, through scientific projects and impact innovation that contribute
The goal of this report is to present the main strategic actions developed by CENBiot (CeNAT-CONARE) in 2023, including the main goals based on the opening, linking, and internationalization actions proposed on the 2019-2024 CENBiot and CeNAT Strategic Plan, as well as the implementation and continuity of the proposals raised in:
to society in the economic, social, and environmental fields, through the exchange of knowledge, services in science, and alliances with the business sector.
The lab promotes internationalization as a strategy to achieve competitiveness, attract external resources, and continuous updating. Its operation mode is based on promoting openness and accessibility to the installed capacity. Academics, innovation managers, public policy makers, and businessmen converge in this innovation hub.


The Improvement and Implementation Plan of CENBiot's 2019-2024 Strategic Plan
The 2024-2028 Strategic Plan prepared during 2023.
The 2021-2025 National Plan for Higher Education (PLANES) of CONARE.
The 2022-2027 National Plan for Science, Technology, and Innovation of the Ministry of Science, Technology, and Telecommunications (MICITT).
59
Strategic Actions
Executed in 2023
During 2023, CENIBiot continued to develop strategic lines that are the basis of scientific production and the most relevant alliances with the productive sector inside and outside Costa Rica.
With CENIBiot Operational funds, strategic lines were favored such as the study of microorganisms, their biology, biological interactions in various ecosystems and their use, mainly in agriculture. Approximately 75% of scientific production is based on these themes. Thanks to these strengths we have been invited to participate in prestigious international events organized by institutions such as WIPO, WAITRO, UNESCO-IEEE Entrepreneurship Workshop, and ACTIVA CATIE, among others. Participation at influential forums such as the International Microbiology Literacy Initiative


(IMiLI) was consolidated and a high-level international event in environmental microbiology was organized. To continue growing, significant resources were invested in developing novel methodologies in metabolomics that in the future will be reflected in more robust and high-impact projects.
60


The prestige, trust and visibility associated with the main lines of research favored important collaborations with private actors in Costa Rica and abroad. Highlights include the conclusion of the first stage of the R&D project in collaboration with Mammoth Biosciences, led by Dr. Jennifer Doudna, Nobel Prize winner in chemistry. The “Large-Scale Microbial Diversity Study in Costa Rica” began with the company Basecamp Research from the United Kingdom, which also donated cutting-edge equipment and training for the academic ecosystem, job creation, and economic benefits for the private sector. Thanks to this alliance we participated at the scientific sessions that took place during the United Nations General Assembly (UNGA78) and the collaboration was publicized in the European media. Also, the company Compound-Foods based in San Francisco-California trusted CENIBiot to accelerate the development of a strategic line of its business plan. Finally, the leadership in the study of biofuels for agricultural use provided us with access to competitive funds from the Adelante2 triangular cooperation program between Latin America and Europe, endowed with more than $70 thousand USD in materials and logistics.


In summary, perseverance in strategically defined lines of research begins to bear the expected fruits in the task of “transforming knowledge into development” alongside the productive sectors, in addition to the growing recognition and academic productivity that has been experienced in recent years.



61

Development Goal


Mission Vision
To generate biotechnological research that contributes to the development of Costa Rica, through scientific projects and impact innovation that contribute to society in the economic, social, and environmental fields, through the exchange of knowledge, services in science, and alliances with the business sector.


We seek to be a biotechnological research and development laboratory that works with high scientific standards and where higher education in Costa Rica, public and private sectors converge to accelerate scientific and technological innovation.

We aim to be a self-sustaining laboratory with high scientific, economic, and social impact at the national and international level that strengthens competitive development through scientific rigor and intersectoral articulation.



62
Values
Enforced at CENIBiot:
Human team care
Ongoing learning attitude
Attitude of amazement at the findings and achievements obtained
Collaborative management in the projects that are undertaken

Principles
Enforced at CENIBiot:
Supportive and efficient use of scientific equipment
Accountable administrative management of research projects
Willingness for constant improvement of the projects that are undertaken
Operating Structure:
Biodiversity / Biomolecules
Bioprocesses
Drug discovery
Microbial communities
Sustainable agriculture
Innovation and Impact
63


Strategic Objectives



To generate solutions based on biological inputs that allow ecological agriculture with technological independence and greater profitability
To understand the composition and kinetics of microbial communities for ecological studies of environmental impact, drug discovery
To conduct research and development projects in bioprocesses to strengthen regional scientific growth and innovation processes



To develop research and development projects that link bioproducts with the evolution and prevention of metabolic disorders and their consequences.
Strategic Nodes
Research in Bioprocesses. Research in Drug Discovery. Research in Microbial Communities.

Research in Sustainable Agriculture.
64
















Indicators PUBLICATIONS 15 14 Indexed 1 Not indexed Indexed by quartile I Indexed by quartile II 13 1 Impact 65












TOTAL 30 26 National (Taught) (Taught) 2 International Courses, workshops, symposiums 2 Private Funds
People benefited 194 66
TRANSFERS KNOWLEDGE


FEES Internal CONICIT funds (Incentive Funds) Private Funds 2 19 2 3 Public funds CeNAT Scholarships: 9 Final graduation works: 41 Student, assistant, and graduate hours: 15 Private Funds Student, assistant, and graduate hours: 7
7 67
Research Projects TOTAL 26
Attention to Students TOTAL 72 65


Linkages


National Academic Sector:
UCR
UNA
TEC
UNED




National and international Universities and Institutes:
International Pharmacy Students Federation (IPSF)
University of Salamanca Monterrey Institute of Technology
National Center for Bioecology of Spain
WAITRO
WIPO
CIRAD-France
CONARROZ
PROCOMER
CATIE
Life Sciences Cluster Biomaterials cluster
International companies:
Nippon Papper
Papylia CR
Boston Scientific
Thrive Natural Care
Cambrium
Mammoth
Biosciences
Compund-Foods
BaseCamp Research



National companies:
Bio CR

Biotech C.R S.A.
CoopeAgri R.L.
CoopeCuna R.L.
CORBANA, S.A.
Corporación de Desarrollo Agrícola del Monte S.A.
Establishment Labs S.A.
Granja Avícola Santa
Marta S.A.
Stein Laboratories Speratum
Stein Corp.
BIOTECH
La Cotinga
Tirimbina Biological Reserve
Pelón de la Bajura

68

Agreements
TOTAL 2
1 National FPP-CV-001-2023 Search for antibiotic-producing bacteria in the Amblipigida Cave of Costa Rica” UCR- CENAT
1 International FP-CV-001-2023 Diversity Study Large-Scale Microbial Diversity Study in Costa Rica (Basecamp Research)
69
Summary of Projects




Public Funded Projects
FPP-FP-001-2023 Selection of phosphorus-solubilizing microorganisms with biostimulant potential in plant growth.
FPP- FP-002-2023 Contamination of Costa Rican corn by toxigenic Fusarium species (FEES).
FPP-FP-003-2023 Effects of endophytic fungi from plant isolates of the Rubiaceae family on the morphology and physiology of coffee plants.
FPP-FP-004-2023 Role of sorcin in lymphocyte in-vitro proliferation.
General description
The range of working concentrations was reduced to achieve a curve with acceptable linearity to assign a quantifiable value for the samples analyzed. The final evaluation of the field trial in coffee is pending.
Sequencing of the samples has been carried out. Additionally, some pipelines for bioinformatics analysis have been refined and data analysis is in progress.
The results of this work resulted in a manuscript that has been published in the Journal of Applied Microbiology, so it has concluded.
As a result of the project, the manuscript was sent for review to the journal Biology Methods and Protocols; However, this was rejected and is currently being submitted to the journal Analytical Biochemistry. In addition, progress was made in the planning and writing of a second article that describes the effects that the transfection vehicle has on the change in lymphocyte activity, which could be an undesired effect or one that could potentially be used as a therapeutic effect for the transfection.
FPP-FP-005-2023 Evaluation of the efficacy of an experimental treatment for Chagas disease using purified fractions from plants of the Hamelia genus, collected in Sarapiquí and the Osa Peninsula.
The structure of the active compounds has been elucidated and mechanism of action experiments for metabolomics are being performed. In addition, sophisticated statistical analyzes are being performed for activity results against amastigotes.
1 2 3 5 4 70
PFP-006-2023 Genetic imprinting of Melina.
FP-007-2023 Initial approach to the bioprocess for obtaining lipoteichoic acid from Lactobacillus rhamnosus GG for future applications.
FPP-FP-008-2023 Development of a food product from microalgae biomass of Arthrospira maxima with high nutritional value (FEES).
FPP-FP-009-2023 Study of the physicochemical and microbiological defense mechanisms of the eggs of Costa Rican forest birds.
FPP-FP-010-2023 Characterizing the microbial communities that inhabit the Amblipigida Cave and evaluating their potential to produce antibioticsSIPPRES.
FPP-FP-011-2023 Verification of analytical balances.

FPP-FP-012-2023 Chemical services catalogue.
FPP-FP-013-2023 Validation of protocols necessary to evaluate the cardioprotective effect of natural products and medications.
FPP-FP-014-2023 Non-targeted metabolomic analyzes.
The data obtained from this project was already generated and processed with its results ready. The student who had been working in the project will not present his thesis due to his resignation from the graduate program; however, the project has already concluded.
Currently the last activity carried out corresponds to the validation of the ELISA kit. The pending activities are application of analytical chemistry on the characterization of the molecule of interest and scaling of the bioprocess.
The experimental stage is now complete. Pending activities are the interpretation of experimental results.
31 samples of microbial communities were received and the data were analyzed. In addition, the molecular identification of 140 samples of the total was carried out, reaching 200 samples identified at least to the genus level. Antimicrobial activity tests were carried out on the remaining samples to complete the total number of samples.
A series of reviews of the collection of active isolates were carried out, regarding antimicrobial activity tests. The manuscript has already been drafted, which will subsequently be submitted to the latest corrections by the other authors.
We proceeded with the implementation of the protocol for the use and verification of scales, the calculation structures, and the verification report (objectives 1 and 2). Subsequently, a review of the generated documents was carried out. The project is finished.

The CENIBiot website is currently being updated (objective II).
Protocols for blood metabolomics and DNA extraction from microbial communities for metagenomics are being established.
The corresponding protocols are in place and work is being carried out in parallel on the procedure for data processing, annotation, and visualization (objectives I and III).



6 7 8 9 10 11 12 13 14 General description Public Funded Projects 71




FPP-FP-015-2023 Quantification of free amino acids by LC-MS/MS.
FPP-FP-016-2023 Analysis of the chemical profile of active fractions of Witheringia solanacea by high resolution mass spectrometry.
FPP-FP-017-2023 Analysis of the chemical profile of alkaloidal fractions of plants of the genus Amaryllidaceae.
FPP-FP-018-2023 Evaluation of potential hydrocarbon-degrading microorganisms isolated from an abandoned oil well located in the Cahuita National Park.



FPP-FP-019-2023 Development of a model of metabolic syndrome in mice.
FPP-FP-020-2023 Optimization of in vitro biocompatibility tests for biomedical devices and biomaterials.
FPP-FP-021-2023 Bioprocesses Laboratory in focus: A visual documentation.

Linearity, repeatability, and reproducibility have been validated and work is being done on the recovery percentage to evaluate the sample treatment.
The data obtained from the project will be used to write the publication, the project is completed.
They were awaiting receipt of the sample to be analyzed sent from Chile on November 20. A manuscript is currently being drafted.
Currently, work continues on the graphic analysis of the assembled genomes. Later, a tool will be applied to detect the genes associated with hydrocarbon degradation and compare each assembled and annotated microorganism at the genomic level.


The project is in the initial stages, so the reproduction of C57BL/6Cr mice is being planned.
The project is in the initial phases, reviewing literature and developing protocols.
The video was recorded with the collaboration of the Base Camp team and the Bioprocesses researchers. The audiovisual material is currently being edited to be published in 2024.

15 17 16 18 19 20 21
72
General description Public Funded Projects

CNCA




(CeNAT-CONARE) 2023 Scientific publicationsDissemination Public Private Total 12 0 12 Knowledge transfer activities 50 1 51 Research Projects 13 2 15 Attention to students Agreements 3 0 3 14 2 16 DISTRIBUTION OF GOALS INDICATORS Cluster operation Cluster usage 85,363 85,363 365 365 74
CNCA Annual Operating Plan
INTRODUCTION

The National Advanced Computing Collaboratory (CNCA) is presented as an interdisciplinary multisectoral environment that connects academia, government, industry, and society. Its distinction lies in the outstanding quality of its research and innovation. This excellence is reflected both in its institutional management and in its philosophy, which highlights transparency and accountability in all facets of its work, from projects to collaborations and knowledge transfers.
The CNCA is a multidisciplinary space where scientific discovery and technological innovation are accelerated, using advanced computing infrastructure. This infrastructure includes not only specialized and updated hardware, but also a set of efficient applications and trained personnel to take advantage of all that technology. This allows CNCA to work on the core dimensions of the development of research projects, training, and service delivery. and


The CNCA is a multidisciplinary space where









The main objective of the CNCA is to provide two fundamental pillars for scientific advancement in the national and international community. In addition to theory and experimentation, the crucial importance of simulation and data analysis in exploring new frontiers of knowledge is recognized. To achieve this goal, computational tools, both hardware and software, are essential. Thus, the members of the CNCA focus on the computing cluster and the applications installed in it, seeking to provide a computational infrastructure of excellence that facilitates the development of projects and services with a significant impact on society.


75
Development Goal
To encourage the use of advanced computing in research, using complex information to boost science and technology development and innovation in Costa Rica.

Mission

We are a laboratory that develops interdisciplinary research through advanced computing to solve complex problems, accelerating scientific and technological innovation.
Vision
We aim to be a self-sustaining advanced computing laboratory with high-end technological infrastructure that generates a high impact both national and international innovation and development.
76
Organizational Values and Principles

Values
Willingness to good human relationships
Willingness to continuous learning
Collaborative innovation at the laboratory work
The core values and principles of the CNCA's actions throughout its activities are presented below: Accelerating Innovation and Development
Operating Structure


Principles
Creativity in knowledge transfer
Permanent communication within the work team
Efficient use of resources
Collaborative management in the projects that are undertaken
Scientific Computing
Artificial intelligence
Bioinformatics
Data Science
Advanced Networks
Computing Infrastructure
High Performance Computing
77
Objectives
Using the critical areas as a basis, the strategic objectives have been developed to provide mechanisms to achieve the established goals:
To develop workflows and methodologies that allow the implementation of computer agents that simulate learning skills or human intelligence
To conduct genomic and metagenomic data analysis
To develop research processes in the application of advanced computing techniques
To develop computational modeling and simulation flows
To develop research processes in the application of methods for managing and analyzing large amounts of data (Big Data)
To promote the use of advanced network services by encouraging academic research and the creation of scientific projects and communities
To develop and monitor the computational infrastructure of the Kabré supercomputer, as well as to provide support to its users
Strategic Nodes
Maintenance of the computational cluster with state-of-the-art equipment.
Development of the professional career for human resources. Fundraising through the sale of services and external research funds. Effective dissemination of results.
Substantial scientific production and development of high impact research projects.
Appropriate training portfolio for different scientific and engineering domains.


78








79
Impact Indicators
TOTAL 51


8 Advanced computing seminars, where an expert in the application of high-performance computing in a particular scientific domain presented their results.
6
4 2 1
Programming training in introduction to programming, scientific computing, and machine learning with the Python language for different scientific domains.
1 Workshop on “Task Parallelism” taught by the laboratory director.
Workshop on “Introduction to C programming (HPC Preschool 2023)”.
Workshops on the use of Kabré and Linux.
Programming training in introduction to programming, statistical analysis and data visualization with the R language for different scientific domains.
Bioinformatics processing training for genomic and metagenomics data.
Workshop on “Adaptive Message Passing Interface” taught by the laboratory director.

Personas beneficiadas:
663



Programming schools on Big Data topics: Costa Rica Big Data School Limón and Costa Rica Big Data School Puntarenas in face-to-face mode.
National presentations at academic conferences, meetings, seminars, and forums.
International presentations on high-end performance computing topics in a national and international scientific domain.
Programming school on advanced computing topics: Costa Rica High Performance School.
1
2 7 12 1
6
80
TRANSFERS KNOWLEDGE IMPARTED










TOTAL 16 Attention to Students 14 Public Funds Scholarships Student, assistant, and graduate hours 6 8 2 Private Funds Student, assistant, and graduate hours 2 81



946
Computational Infrastructure
365




accounts with access to computing infrastructure services
science hours in simulations and data processing
110% days a year of operation of computer services that resulted in:
85,363 of the availability of the computing cluster service
FEES-funded Projects Internal projects CONARE-funded Projects Computational science and parallel and distributed computing research projects. 3 8 2
Research Projects TOTAL 15
13 PUBLIC FUNDS 2 PRIVATE FUNDS
82
Linkages
The laboratory has achieved linkages with the following institutions and organizations

MICITT-CONICIT
MINAE

MAG
Ministry of Health
Public Universities (UCR, TEC, UNA, UNED, UTN)
INA
Professional associations (CPIC)
MOPT
ICT Chamber
Lawrence Livermore National Laboratory
SCALAC
BSC
CSUCA
Association of Professionals of CGR
JUPEMA
INTA
CENIA (CHILE)
ICE
UCIMED
Ministry of the Presidency
Civil Aviation
Min. Public Security
Banco Popular
INEC
Ministry of Foreign Affairs
Ministry of Public Education
CONAVI
Chamber of Industries of Costa Rica
LANAMNE
Treasury
Procomer
CINDE
CNFL
COMEX
Ministry of Housing and Human Settlements
Comptroller General of the Republic
National Institute on Agricultural Technology Innovation and Transfer
RECOPE
SENARA
AYA
Chamber of Tourism
ICT Chamber
ICAFE
Work Unions
CGR Professional Guild
CANAPEP
CANAPALMA
CORFOGA
Cooperation International US Navy
Lawrence Livermore National Laboratory
SCALAC
BSC
CPIC
83
Agreements
RedCONARE
One of the services of RedCONARE and the ICT departments of the universities is Eduroam, which has the following indicators: TOTAL 2
National agreements to work in the field of advanced computing.



Network services are available to approximately 125,000 students, staff, and teachers
Access to Eduroam internationally in 106 countries that participate in the deployment of the connectivity network
There are more than 2 billion authentications of the Eduroam network in international territories
Eduroam network deployed in the headquarters and campuses of the five public universities. Research centers and the CONARE-CeNAT building
84




Summary of Projects

Project
Analysis of the microbial plasmidome in contaminated water and its possible effects on health and the environment
RedCONARE
Data Science Desk
General description
This project seeks to characterize the diversity and typology of the set of plasmids (plasmidome) in the water column, the sediment, and polystyrene microplastics exposed at different points in the Virilla River basin, so it is proposed to generate novel scientific information on the ecology. of plasmids in aquatic environments, and the effect of contamination on the transmission of these and their genes of importance for public health
The main objective of advanced networks is to serve as a fundamental tool to promote scientific research, improve health through medical education, research, and telehealth, as well as enhance education through the efficient storage and distribution of content. educational, facilitate inter-institutional collaboration, allow access to remote instruments and laboratories, and offer network services that facilitate connectivity and data transfer in an agile and secure manner
The objective of the Data Science and Visualization working group is to promote a broad research process that ranges from in-depth knowledge of the subjects under study to the effective communication of results through visualizations. This involves collecting data from digital sources, using programming techniques to organize the information, and sophisticated statistical analysis. By adopting this approach, we seek to establish a new way of retrieving and analyzing information in an expeditious and accurate manner. This will allow a more complete approach to issues related to human development, using innovative sources of information to advance understanding and informed decision-making
1 2 3 FEES-FUNDED PROJECTS 85
Project
Advancing plasma physics computer simulations with the latest high performance computing techniques
Uncovering novel microbial symbioses occurring in wasps and beetles from Costa Rica
General description
The objective of this project lies in understanding the impact of the latest technologies in parallel programming for plasma physics simulations, both from a performance and programming point of view
The main objective of this project is to explore and describe in detail the symbiotic relationships between insects and microbes. This approach is based on the interest shared by research groups, who have investigated the chemical evolution, ecology, and molecular interactions in insect-bacteria symbioses, as well as their potential application in agriculture and tropical medicine. This project seeks to deepen the understanding of these symbiotic relationships, identifying new perspectives and applications in the field of microbial ecology. This research will contribute to the advancement of knowledge in this field and will lay the foundation for future research in the area

General description Project
Machine Learning applied to bioaquatic recognition of tropical birds
Applying deep learning models is proposed to detect and classify various species of tropical birds from available audio files, exploring and preparing the formats of these files in the repositories of bird songs for subsequent analysis in the recognition of species in Costa Delicious. The aim is to identify and compare different deep learning mechanisms for this purpose, with the aim of finding the most reliable technique. The aim is to build a workflow for a bird song recognition and classification system, considering the available file formats and the selected deep learning techniques, as well as the processes necessary for the classification and labeling of songs. This workflow will be evaluated with real data from bioacoustic repositories by analyzing the performance of the system in terms of precision and accuracy, identifying possible improvements for future implementations
1 2
CONARE-FUNDED PROJECTS
1
INTERNAL PROJECTS
86
INTERNAL PROJECTS
Project

advanced networks
General description

GPU-accelerated RICH Decoding in Allen


computing, high-performance computing, and advanced networking. The current state of digital twin technology and its potential implementation in specific sectors of national interest will be examined. The study will be limited to specific components related to modeling, simulation, high-performance computing or advanced networks. Subsequently, a prototype will be developed that integrates some of the main components of digital twins. In addition, alliances will be sought with universities and organizations interested in promoting research and applying this technology for the benefit of the relevant national sectors

The main objective of this project is to develop a GPU algorithm within the Allen framework for the decoding of detections in the LHCb RICH detectors. This will be achieved by creating an initial implementation of the RICH code on CPU, which will work within the Allen-GAUDI framework. Subsequently, an implementation of the RICH code will be carried out on GPU for the standalone Allen framework, thus taking advantage of the massive processing potential offered by graphics cards. Finally, work will be done on optimizing and parallelizing the RICH code in Allen for execution in a cluster with GPUs, which will allow greater efficiency and speed in data processing from the LHCb's RICH detectors. This project aims to significantly improve the performance and data analysis capabilities of the RICH detectors, thereby contributing to the advancement of particle physics research at the LHCb

5
87
Development of artificial intelligence tools for the analysis of electrocardiographic data
Improvement of the Kabré computing platform
The development and implementation of advanced computational solutions is proposed to facilitate data analysis and the application of artificial intelligence for the detection of anomalies in electrocardiographic records. This will include a comprehensive study of the state of the art to identify AI-based solutions. A training and labeled database will be established containing electrocardiographic recordings for further analysis. An AI model capable of identifying heart diseases and other related conditions will be developed by automatically analyzing electrocardiographic data collected from medical centers in the country. This approach will improve early detection and accurate diagnosis of heart disease, which could have a significant impact on the cardiovascular health of the population
The refinement and optimization of the administration, security and accessibility systems of the Kabré cluster's computing resources is proposed with the aim of reducing waiting times in job queues, improving system security and more efficiently managing the available resources. This will include optimizing the response time of file systems such as NFS and LUSTRE, implementing better accessibility mechanisms through platforms such as Open OnDemand, and optimizing the SLURM resource management tool. In addition, the security of the platform will be strengthened through the implementation of monitoring systems and the introduction of two-factor authentication. These measures will work together to improve the efficiency, security, and accessibility of the Kabré cluster, benefiting users and maximizing system performance
Hydrographic simulation in river hydraulics on GPUs


Setting a complete simulation flow that includes the generation and analysis of watershed data is proposed to evaluate the risk of flooding in Costa Rican regions. This workflow will involve the development of a hydrological simulation of rivers using the SERGHEI code on GPUs, adapting it for efficient execution on this type of processors. Hydrological simulations of several rivers in the country will be carried out to understand their dynamics under various conditions. Subsequently, a post-processing and visualization environment for hydrological data will be developed in Python, using tools such as Xarray, Matplotlib, and NumPy to facilitate the analysis of the results obtained. In addition, another module will be added to the SERGHEI code to solve the Exner equation, considering sediment transport and erosion, which will allow a more complete and precise evaluation of the behavior of rivers in relation to the risk of flooding in the Costa Rican regions


6 7 8 INTERNAL PROJECTS
88
General description Project


PRIVATE FUNDS PROJECTS




General description Project







The main objective of the RISC2 project is to foster stronger cooperation between the industrial and research communities in High Performance Computing (HPC) applications and infrastructure deployment, in a context where the widespread use of HPC is generating new benefits in areas such as industry, healthcare and the economy. To achieve this goal, the project will bring together eight key European HPC players, along with leading HPC players from Brazil, Mexico, Argentina, Colombia, Uruguay, Costa Rica and Chile. This collaborative effort will be guided by an external Board made up of leading experts from Latin America and Europe. RISC2 will promote the exchange of best practices through meetings, workshops, and training events, organized to coincide with major HPC events in Europe (such as ISC and EuroHPCSW) and in Latin America (such as CARLA and ISUM). This approach seeks to strengthen coordination and exchange of capabilities between allied regions, recognizing the strategic importance of intense investments in HPC to maintain global competitiveness
The objective of the project is to carry out a regional characterization of the waves of Covid-19 infection cases in Costa Rica and Guatemala. This analysis seeks to understand the dynamics of the disease in these regions through detailed study of the available epidemiological data. The aim is to examine the geographical distribution of cases, the temporal evolution of infection waves, incidence rates and the severity of outbreaks in different areas. In addition, it seeks to explore possible correlations with demographic, socioeconomic, and public health variables to identify factors that may influence the spread and impact of the virus in each country. This comprehensive approach will help inform public health decision-making and guide the implementation of Covid-19 control and prevention strategies in Costa Rica and Guatemala
RISC2: A network for supporting the coordination of Computing research between Europe and Latin America
Central American Network for Management of Epidemiological Data
1 2
89

PRIAS










Public Private Total 1 4 3 16 1 11 0 3 0 14
Annual Operating Plan (CeNAT-CONARE) 2023 GOAL PROGRAMMING INDICATORS 91
PRIAS
INTRODUCTION
PRIAS is a Geomatics laboratory with an emphasis on Earth Observation that provides the country with high-precision information available to all users worldwide, with the aim of addressing challenges and promoting studies on the national and international territory. Attached as a Laboratory to the Centro Nacional de Alta Tecnología (CeNAT), it is a program of the Consejo Nacional de Rectores (CONARE), it conducts the promotion and development of scientific research activities in various fields.
The PRIAS laboratory is a national link for scientific airborne missions, which uses Earth Observation techniques to carry out environmental and cartographic studies that generate relevant information for decision makers and creators of national and international public policies. Its creation enabled Costa Rica as one of the few countries in the world to have a collection of aerial photographs, with different sensors, which has recorded more than 80% of the territory. In addition, the synergy created between institutions in those early years promoted the triple helix development model that continues to this day, and which has an implicit impact and multiplier effect on the efforts made in the Costa Rican territory.
PRIAS is comprised of a multidisciplinary work team and maintains a close relationship with institutions in the academic, public and private sector at a national and international levels. It aims at the promotion of scientific research and transfer of knowledge, through the acquisition, treatment, storage, analysis, representation, and dissemination of information in the areas of Photogrammetry, Remote Sensing, Geographic Information Systems, Global Positioning System, Spatial Data Infrastructure, Geodesy, and Computer Science, which constitute the which constitute Geomatic Science.

This report concentrates the activities carried out during the year 2023, which show achievements and important progress made in the seven large areas of Geomatics mentioned above and with applications to Earth Observations, as well as the linkage with the academic-public-private sectors.
92

Development Goal


To develop research in earth observations that contribute to the knowledge of the Costa Rican territory through applied geo-aerospace science projects that promote decision-making capacity in the academic, socioeconomic, and environmental fields.


Mission




We are a research laboratory in earth observations made up of a specialized team of professional people who work with the highest scientific standards, articulated with higher education in Costa Rica within the framework of innovation with the public, private, social and economic sectors. International cooperation.
Vision
We aim to be a self-sustaining scientific research laboratory that provides high-value knowledge on issues of innovation in geospatial management, aerospace catalyzing and geoinformatics development, at an academic, socioeconomic and environmental level in the region.
93
Values
Enforced at PRIAS
Effective communication in collaborative work
Willingness to multidisciplinary learning
Creativity to face improvements
Commitment to the goals set in each project
Openness to change management


Principles
Enforced at PRIAS
Efficient use of technological infrastructure
Interdisciplinary collaborative work
Knowledge transfer adapted to populations
Willingness for constant improvement of the projects that are undertaken

Geospatial management
Operational Structure:
Geo-informatics Development
Innovation in Earth Observations
Catalyst Aerospace Technology
94
Strategic Objectives
To strengthen the management and scientific rigor of geospatial data for data-based decision making
To generate IT solutions to optimize geospatial data systems
To integrate the development of transformative technologies and sciences for the rigor of knowledge and prospective decision making


Geographic Information Systems
Global Positioning System
Computational Science Spatial Data Infrastructure
95



















PUBLICATIONS TOTAL 4 3 Indexed 1 Specialized
96
Indicators
Impact










TOTAL 16 7 National TRANSFERS KNOWLEDGE People benefited: 568 Workshops Lectures Symposiums 3 3 1 9 International Workshops Congresses 1 8 Workshops and/or courses at Universities Presentations, symposiums, conferences CEC: 230 GLOC: 15 RIAO Optilias: 18 TEC: 20 Environmental Education Experiences: 50 AMERIGES: 135 PRIAS event: 43 57 511 97


Projects TOTAL 11 Internal Operational PRIAS CeNAT 9 1 TOTAL 14 Scholarships Interns Final Graduation Works Assistant Students 8 1 1 4 Attention to Students 10 Public Other funds 1 1 Private Proposal Spectroradiometry of Archaeological Salt Flats in Salinas Bay Proposal for SDG Indicators 11.3.1 and 11.7.1
for priority sites Korea-LAC Tech Corps
Projects under negotiation 98
Research
Proposal
4



Linkages
10
National Academic Sector
Costa Rica Institute of Technology University of Costa Rica
State Distance Education University
National University of Costa Rica
National Technical University
International universities or institutes
United States Agency for International Development (USAID)
Central American Aeronautics and Space Association (ACAE)
Inter-American Development Bank (IDB)
German Aerospace Center (DLR)
Copernicus Reference Center of the University of Chile
Global Environment Facility (GEF)
Global Fishing Watch
Google Earth Engine
Natural Capital Project
Food and Agriculture
Organization of the United Nations (FAO)
United Nations Development Program (UNDP).
Secretariat for the Group on Earth Observations (GEO)
Central American Integration System (SICA)
Regional Visualization and Monitoring System (SERVIR)
System for Earth Observations, Data Access, Processing & Analysis for Land Monitoring (SEPAL)
International Union for Conservation of Nature (IUCN)
Mexico Civil Protection School (ENAPROC)
RSTAG
Texas Tech University
Sevilla University
Florida International University
AMEXCID
22
72 99
TOTAL
National Universities or Institutes
Tropical Agricultural Research and Higher Education Center (CATIE)
National Center for Geoenvironmental Information (CENIGA)
National Commission for Risk Prevention and Attention to Emergencies (CNE)
National Commission for Biodiversity Management (CONAGEBIO)
Environmental Quality Management Directorate (DIGECA)
General Directorate of Civil Aviation
National Forest Financing Fund (FONAFIFO)
Costa Rican Coffee Institute (ICAFE)
Inter-American Institute for Cooperation on Agriculture (IICA)
National Meteorological
Institute of Costa Rica (IMN)
Costa Rica National Institute of Statistics and Census (INEC)
National Institute of Agricultural Technology (INTA)
Ministry of Agriculture and Livestock (MAG)
Ministry of Environment and Energy (MINAE)
Ministry of Housing and Human Settlements (MIVAH)
Municipality of San José
State of the Nation Program (PEN)
SIRGAS Network (Geocentric Reference System for South America).
National Registry of Costa Rica Sectoral Planning Secretariat of Environment, Energy, Ocean, and Territorial Planning (SEPLASA)
REDD Secretariat (Reducing Emissions from Deforestation and Forest Degradation).
National System of Territorial Information (SNIT).
National Monitoring System for Land Cover and Use and Ecosystems (SIMOCUTE)
Administrative Environmental Court (TAA)
RedClara
National Museum
Aerospace Engineering Group
National Power and Light Company
Tropical Scientific Center
Clodomiro Picado Institute
Environmental Educators Network
OTS
MICITT
National Institute of Housing and Urbanism

34 100
8
International Companies
EO Data Science
Planet Inc.
Space Generation Advisory Council
UNAQ
Orbital Space Technologies
Astralintu Space Technologies
NASA Space Apps Challenge
International Astronautical Federation





101


Agreements
TOTAL 3
National Municipality of San José Tropical Scientific Center Administrative Environmental Court
102




Summary of Projects

Library of Spectral Signatures
PRIAS Spatial Data Infrastructure
Implementation
Unmanned Aircraft for Research (UAV)
To leverage GeoCenter resources for the implementation of a distributed system of orchestration and container technologies within the PRIAS data center, which allows the automation of the deployment, scaling and management of containerized applications within the PRIAS data center
Development of a tool that allows cataloging, managing, and sharing spectral signature data collected in different internal and external research projects. As well as supporting the range of research in the country by accompanying interns, CeNAT-PRIAS scholarship holders or practitioners and collaborating in the generation of hyperspectral data information from institutions within the triple helix
To develop a web implementation of spatial data infrastructure by optimizing the use of the GeoCenter to offer a variety of services, as well as an inventory system for the laboratory assets, and hosting and monitoring of the different GeoCenter services
To generate data for research through the use of UAV's and photogrammetry. In addition, it seeks to support the range of research in the country by supporting student interns, the CeNAT-CONARE scholarship program, interns, and projects from the PRIAS laboratory, and collaborating in the generation of photogrammetric data information from institutions within the triple helix
Implementation of distributed storage in data center
1 2 3 4
Project PUBLIC FUNDS | Internal Projects
General Description
General Description Project
Reforestation from the air
The forest fire regime in Costa Rica possible strategies for mitigating its impact on the tropical dry forest
Spatialization of the tree flora of Costa
Development of tools to reforest from the air with rocketry as a dispersion mechanism and methodology to measure the progress of reforestation
To analyze fire behavior through fire regime variables to generate predictive models of the spatial distribution of forest fires that provide strategic information in mitigating damage in the tropical dry forest
It is developed in conjunction with the State Distance University Development

of a pilot project to map the tree flora in the Greater 5 6 7
PRIAS
development of this project is linked to the fulfillment and development of the different operational indicators of the laboratory 5
Operational
The
PUBLIC FUNDS | Internal Projects
General Description Project
General Description
Local productive structures: productive, labor, and territorial value chains in Costa Rica
Cantonal Historical Geospatial Representation of Costa Rica for the 1905-2014 period
Building the spatial representation in the form of geographic information layers that allow reproducing the historical analysis of the Protected Wilderness Areas from 1955 to the present, with the aim of linking it with other socio-environmental variables
Building the spatial representation in the form of geographic information layers that enable reproduction of the Territorial Administrative Division of Costa Rica for the periods 1905, 1950, 1963, 1973, 1984, and 2014


PRIVATE FUNDS
Project
Digital system for monitoring illegal logging in the Golfo Dulce Forestry Reserve and a study area on the Pacific side of La Amistad National Pilot Project


General Description
Developing a methodology that could be implemented within a Digital Illegal Logging Monitoring System that will allow governments to better manage resources in the fight against illegal logging, corresponds to joint research between the PRIAS laboratory and the United Nations. United Nations for Food and Agriculture
1 2 PUBLIC FUNDS | Joint Projects with the State of the Nation Program (PEN)
1
Project
NASA Space

The PRIAS laboratory participated in the NASA Space Apps Challenge competition through the infrastructure analyst Stephanie Leitón, the intern student Andrés Aguilar (PRIAS Laboratory), the former scholarship recipient Andrea Hidalgo from the CeNAT-CONARE program plus the participation of students from the Engineering Group Aerospace from the UCR, and a software developer.

In this competition they obtained first place locally in Costa Rica and were nominated to participate for a prize in the global competition.
Through this participation, it was possible to generate knowledge that is the basis for the formation of the approach of the Creative Space project of the PRIAS Laboratory.
PRIAS 20 years building Geospatial Research

PRIAS is the first laboratory of the Centro Nacional de Alta Tecnología to celebrate 20 years of dedication; within science and technology, to transform knowledge into development to support informed decision-making based on data and collaborating in the democratization of information.
On November 27, 2023, the commemoration event was held with the purpose of celebrating 20 years of dedication and achievements, as well as reflecting on the milestones achieved and the future of geospatial research. The event had the presence of ambassadors, directors of public, private and international organizations, university authorities, and researchers with extensive experience.

Ambiental
Gestión







Scientific publicationsPublic Private Total 2 0 2 15 5 20 2 5 7 2 0 2 8 3 11 Environmental Management Annual Operational Plan (CeNAT-CONARE) 2023 DISTRIBUTION OF GOALS INDICATORS 109
INTRODUCTION



The Environmental Management Area links and articulates environmental, climatic, and agromatic actions among the universities linked to CONARE, state institutions, and the business sector. Topics include advisory and search for sustainable alternatives in productive processes, natural resources, best practices, academic and specialized training activities, research, and applications of new environmentally-friendly technology. This area is supported by Environmental Management representatives from UNED, UNA, ITCR, UTN, and UCR, which make up the Academic Advisory Committee.


Its main goals include support, coordination, and projection in Environmental Management at universities; development of environmental projects and interdisciplinary activities with the other divisions at CeNAT; management and conservation of natural resources, climate, and food safety; and support in improving the country's environmental policies.
110
Development Goal
To disseminate and empower society in the economic, social, and environmental fields on climate change, productive chains, and added value of products, by developing technical assistance processes that territorially impact innovation projects, technology, and entrepreneurship for the productive development of Costa Rica.
Vision
Mission

We are a research area with national and international linkages, which supports the public, private, and civil society sectors in technical assistance for decision-making in the face of risks of weather events and in productive development, through a team of specialized professionals who carry out studies with the highest scientific standards, within the framework of innovation and development of higher education in Costa Rica.
We aim to be a self-sustaining research area with high economic and social impact at the national and international levels, which contributes to knowledge generation on climate change, production chains, and product added value, being a leader in strengthening competitive development and technical assistance from the intersectoral articulation.
111

Values enforced at the Environmental Management Area
Human team support
Support to food industry and productive support in continuous improvement
Collaborative management in the projects that are undertaken
Socialization of scientific information to society



Principles Enforced at the Environmental Management Area
Efficient use of time
Accountable administrative management of research projects
Willingness for constant improvement of the projects that are undertaken
Knowledge and skills empowerment


112
Operational Structure:
Strategic development areas of Environmental Management
Innovation and development
Technical assistance

Climate change
Agromatics
Clean energies
Strategic Objectives of the Environmental Management Area


To provide technical information on atmospheric variability and climate change to the productive decision-making sectors of Costa Rica and Central America
To generate collaborative actions with communities of agricultural producers in processes of improvement and added value of products
To promote the development of sustainable energy transformation technologies and solutions in coordination with national and international actors
To increase knowledge in communities on environmental management matters
To strive to the financial sustainability of Environmental Management
113

Strategic Nodes of the Environmental Management Area
Development of computer platforms and information access tools for decision makers, producers, and communities, on population, spatial, environmental, climate, and agrifood matters
Development of joint projects to support communities and environmental impact studies with national and international organizations
Promotion of knowledge and added value of products through agromatic strategies linked to national, regional, and global initiatives, such as the SAN-CRLAC plans, Slow Food, denominations of origin, Mother Earth fairs, and related activities
114
Programs of the Environmental Management Area
General Coordination
The Direction of the Area supports and aligns the strategic actions of the different programs that make up the Area. In addition, it collaborates in managing the projects developed by PRIAS Laboratory.
Furthermore, it promotes business innovation actions and projects with European and American linkage projects, focusing on SMEs and high-tech ventures. This is done in association with the Ministry of Science, Technology and Telecommunications (MICITT) and the Ministry of Economy, Industry and Commerce (MEIC).
Also, -following instructions by CeNAT's General Directorate-, the Climate Observatory Director coordinates the annual CeNAT– CONARE Scholarship Program, focusing on undergraduate and postgraduate students from public universities, so that they can carry out their theses or research projects at CeNAT laboratories and/or programs.
Finally -also under the advise of CeNAT's General Directorate-, it supports the logistic development of inter-laboratory projects and events (congresses, seminars, and others) of other CeNAT units.

115
Climate Observatory
The Climate Observatory Program of the Environmental Management Area responds to the need to strengthen the capacity to adapt to the variability and climate change that extreme variations in weather and climate generate on the productivity of the agricultural sector.

It is a Program dedicated to researching past and current situations, as well as climate perspectives with the purpose of social benefit facing climatic adversities.
The Observatory continuously and innovatively provides services to the agricultural sector in research and training, with personalized assistance from a technological platform on issues related to adaptation and resilience to variability and climate change to agricultural communities, in order to sustain productivity and increase the yield of crops and livestock; thus, helping in decision-making and planning of activities.
116
The Agromatics program is dedicated to working with the support of alliances and high technologies (with universities, institutions, ministries, companies, regulatory bodies, and CeNAT's own laboratories), in

Both products and their gene expression are typified to detect genes for adaptation to the environment and resistance to diseases and pests, which are linked to quality and hardness, according to the variability of the existing species. Typification is done through the knowledge of the organoleptic and culinary quality of local products, many of which are little known.
In addition, morpho-agronomic, physicochemical, organoleptic, and biochemical characterizations are carried out to allow knowing and evaluating both nutritional and anti-nutritional contents of products and, through high technologies, the technical specifications that may indicate that a product deserves a distinctive sign of quality are endorsed. The aim is to determine the origins and uses of the different products and the good use of agro-industrial by-products. These comprehensive studies make it possible to address natural disasters, climate variability and change, deforestation, and loss of harvests that cause higher prices of products and food insecurity.
Through the alliance with Slow Food, activities are developed to promote quality, clean products (innocuous and with clean technologies that minimize damage to human, animal, and environmental health), and fair pricing, by reducing intermediation chains in a way that not only producers and their families win, but also co-producers, who are conscious consumers and understand the problems of producers and their families and consider the great effort they make to provide more sustainable and healthy products.
117
















PUBLICATIONS
Specialized
118
Indicators
TOTAL 2 2
Impact








People benefited:


Attention to 23 WhatsApp groups, 13 Telegram groups, PIACT platform, and Facebook page.



TOTAL 20 15 Public National (Taught) TRANSFERS KNOWLEDGE Lectures Taught Workshops, Discussions, Courses taught 6 8 5 Private National (Taught/Received) Lectures Taught Workshops, Discussions, Courses taught 2 3 International (Taught) Courses and symposia taught 1
More than 9,000
119
Research Projects
TOTAL 7
IDB: Carrying out training workshops to strengthen the General Consultation Mechanism of the indigenous peoples of Costa Rica
Erasmus+ funds to strengthen Central American capacities

Projects/Proposals Under Negotiation TOTAL

11 Attention to Students 2 Public 5 Private CeNAT-CONARE Scholarships CeNAT-CONARE Fellow students 13 3 Assistant Hours Assistant students working by hours 13 3 Student Hours Student working on student hours 12 2 Private 3 120
Linkages

9

National Academic Sector
National Learning Institute (INA)
University of Costa Rica (UCR)
Costa Rica Institute of Technology (TEC)
National Technical University (UTN).
Technical High School of San Sebastian
ULACIT
Santo Domingo High School
Los Tajos wastewater treatment plant
Costa Rican Network of Sustainable Educational Institutions (REDIES)
5
International universities or institutes
Mondragon University, Spain
OEI
EU-SOLARS ERIC
LifeWatcha ERIC
OBREAL
3
International Companies
Rawsuns Technologies – China
Canadian Embassy
The Congress of the Americas on International Education (CAEI)
7
National companies
MICITT
Costa Rican Promoter of Innovation
National Bank of Costa Rica (BNCR)
MEIC
National Learning Institute (INA)
National Bank of Costa Rica (BNCR)
Chamber of Industries of Costa Rica
Banco Popular y de Desarrollo Comunal
121


Agreements
TOTAL 2
122
National Bank of Costa Rica Agreement of the Atlantic campus of UCR National 2




Summary of Projects

Project “Generation of agro-industrial capacities and creation of a comprehensive unit (physical-chemical, organoleptic, and microbiological characterization) to improve the production process of Turrialba cheese with Designation of Origin (PINNASOPROA)”
The Environmental Management Area provides technological support and truthful, pertinent, and timely information to more than 7,500 producers in Costa Rica and Central America, for proper decision-making
Likewise, comprehensive quality units and productive support are developed for producer associations. The Environmental Management project has students who provide a very important contribution in the day-to-day work of different activities and projects that are developed in the Area and its Programs
In this project, the design of the mobile laboratory powered by clean energy was continued and concluded. The different components and systems for both the conversion to electricity and the photovoltaic complementary power supply were also quoted and built. Finally, the shipment of the components developed in China was coordinated and the purchase of spare parts and other equipment is being coordinated with local suppliers
After a year of negotiations, on December 20, 2023, the resumption and extension of the project was achieved until December 31, 2024. A coordination process began with the Presidency of ASOPROA to continue the purchase of equipment, implementation of the Comprehensive Quality Unit (ICU), and intellectual protection of the by-products obtained
General description Project Environmental Management Project Costa Rica - Antarctica Project
1 2 3 123
Project
Earth Market Project

UPS Environmental Management Project
CSUCA Project: “Strengthening environmental competencies in communities through technological and methodological innovation to promote resilience in disaster risk management and climate change in the canton of Heredia, Costa Rica, in the district of Almirante, Bocas del Toro , Panama and the Achí indigenous community, from Rabinal in the Department of Baja Verapaz, Guatemala.”
OEI project of "ENERGYTRAN: EULAC FOR ENERGY TRANSITION: RESEARCH INFRAESTRUCTRES COOPERATION FOR ENERGY TRANSITION BETWEEN EUROPE AND LATIN AMERICAN AND THE CARIBBEAN COUNTRIES"
General description
Training sessions and promotional activities have been held with producers and farmers, in Tucurrique, Turrialba, and the Caribbean area, among other places in the country. The 2024 Earth market is being coordinated and support work has increased in the PIAM. For this project, the land market fair is scheduled for December, after many years of not being able to carry it out. It is a very important activity that involves chefs, artisans, and students, among other people who are very much engaged in the added value of local foods and food security
The professional services of the people who support the PIACT page and manage WhatsApp for the climate perspectives were renewed. In addition, the execution of activities, tours, and related activities of other projects, especially billing the work hours carried out by the area in the PINN project, has been achieved.
In this quarter, the hiring of people who are supporting the PIACT page and chat groups has continued
The project was approved, and the first disbursement has been managed. The work plans and the first materials for the workshops were developed. Also, the first profiles for the project contracts were generated
The proposal was presented and approved by the European Union. Administrative procedures and planning began with LifeWatch ERIC as leader of the work packages in which CeNAT is participating. Work was carried out on the methodological scheme of the project
4 5 6 7 124

SUPPORT IN KNOWLEDGE TRANSFER



In addition to its focus on research development, for LANOTEC is also essential to maximize work in the area of extension and teaching, by giving special attention to developing and enhancing the promotion of scientific vocations in students from an early age, seeking a rapprochement with educational centers to involve children in the process from the first school cycle.


Part of the commitment in this area is evident in the participation of student delegations in the various Science and Chemistry Olympiad, starting the process at the national level to select the representatives to participate in events at the international level.
At the national level, we were involved in the organization of these activities:
XXIII Costa Rican Chemistry Olympiad
V Costa Rican Science Olympiad



VII Camp for the Promotion of Scientific Vocations, mainly Chemistry
In 2023, the following activities were carried out at the international level:
XV Central American and XIII Caribbean Chemistry Olympiad
XXVI Iberoamerican Chemistry Olympiad
55th International Chemistry Olympiad
20th International Junior Science Olympiad


This year a step has been taken to return to presence, by holding 3 Olympiad events in person - Central American and Caribbean Chemistry Olympiad, the International Chemistry Olympiad, and the International Youth Science Olympiad. The Ibero-American Chemistry Olympiad was held virtually.



126
XXIII Costa Rican Chemistry Olympiad
The event was held in person. In addition, category A 28 students took a laboratory exam aimed at those who obtained the best grades in the final exam.

This process involves preparation and revision of tests, participation at events, and contribution to logistics of activities.
In addition, preselected students are trained to prepare for international competitions. During this process, several "super finals" are made to select those who will participate in the international Olympiad.
In 2023, the distribution of participants at the Costa Rican Chemistry Olympiad was as follows:
Students Total of Institutions 80 Category A Alajuela Category B 151 165 316 302 233 535 Total of Students 851 18 Heredia 15 Limón 8 Cartago 7 San José 20 Puntarenas 6 Guanacaste 6 Number of institutions by province 127
V Costa Rican Science Olympiad

The Olympiad was held in a mixed way, with the first exam taken virtually and the final one in person. In addition, a laboratory internship was carried out with the students who obtained the best grades in the final exam. In this internship, students carried out a laboratory practice and after that, they visited some laboratories where they learned about what the laboratory does and what its scope is.
During this process, the exams that have contents from the three areas biology, physics and chemistry are prepared and reviewed, in addition to participating in the activities and managing the logistics of the entire contest.
On the other hand, an annual training course is carried out for pre-selected students to prepare them for the international competition. During this process, a "super final" is held to select those who will participate in the international Olympiad.


In 2023, the distribution of participants at the Costa Rican Science Olympiad was as follows
Students Category A Category B 178 132 310 46 32 78
128











Total Ninth grade Eighth grade Seventh grade Sixth grade Fifth grade Fourth grade 105 106 99 42 23 13 388 Level Students Total of Institutions 39 Alajuela 7 Heredia 9 Limón 3 Cartago 5 San José 12 Puntarenas 2 Guanacaste 1 Total of Students 388 Number of institutions by province 129
VIII Camp for Promotion of Scientific Vocations, mainly Chemistry
This camp was carried out with the finalist students from the Costa Rican Science and Chemistry Olympiad. After conducting an analysis of the candidates, a group of students from all over the country were selected.
During three days, there were lectures, laboratories, experiments, and recreational activities focused on chemistry, physics, and biology, in addition to working on critical thinking and problem solving.
In 2023, the participants in the camp were distributed as follows




Male 23 Female 16 Total 39 Olympiad Students Sciences Chemistry Total 17 22 39 130
Achievements:
XVI Central American and XIII Caribbean Chemistry Olympiad
The Olympiad was held in El Salvador from September 2 to 7 and the members of the Costa Rican delegation were:
Andrea Rivera Álvarez, Head of Delegation
Mario Villalobos Forbes, Mentor
Fabian Andrés Flores Alvarado, Student
Isaac Herrera Chaves, Student
Gloriana Carrillo Cabezas, Student
Jorjan Alejandro Madrigal Ugalde, Student

Gloriana Carrillo Cabezas Bronze Medal
Isaac Herrera Chaves Bronze Medal
Fabián Andrés Flores Alvarado Bronze Medal
Jorjan Alejandro Madrigal Ugalde Silver Medal
131
XXVII Iberoamerican Chemistry Olympiad

The written test was performed in the same way by the OlyExam platform and the students had five hours to complete it in one of CeNAT's meeting rooms. The discussion, translation, and subsequent test reviews went off smoothly.
The Olympiad was organized by Ecuador and was held from October 02 to 19, 2023. The Costa Rican delegation was made up of:
Wendy Villalobos González, Head of delegation
Eduard Ríos Badilla, Mentor
Fabián Flores Alvarado, Student
Jorjan Madrigal Ugalde, Student
Henry Mora Ureña, Student
José Daniel Muñoz Solís, Student
Andrea Rivera Alvarez, Supervisor
Logros:


The Olympiad was held virtually, using the Zoom, Google Drive, and OlyExam platforms. In addition to the protocol activities, they were broadcast on YouTube.

The meetings for discussion of evidence, translation, and decision making were held on the streaming platform. The laboratory test was done through explanatory videos uploaded to Google Drive and the exam document was downloaded and printed through the OlyExam platform. This test was performed at the CeNAT Computer Laboratory.
Jorjan Alejandro Madrigal Ugalde Silver Medal
Fabián Andrés Flores Alvarado Bronze Medal
José Daniel Muñoz Solís Bronze Medal
Henry Mora Ureña Honorable mention
132
55th International Chemistry Olympiad
The event was held in Switzerland, from July 16-25, 2023. The Costa Rican delegation was made up of:


José Roberto Vega Baudrit, Head of Delegation
Manuel Sandoval, Mentor
Randall Syeed, Companion, with own funds
Juan Pablo Hernández Abarca, Student
Henry Mora Ureña, Student
José Daniel Muñoz Solís, Student
Alexander Sancho Dive, Student

Achievements:
Although no medals or prizes were awarded, the commitment, participation, and growth of the students at an academic level during the development of the Olympiad was highlighted.
133
20° International Junior Science Olympiad


This Olympiad was organized to be held in person. The discussions, translations, and judgments were made by the mentor professors of the delegation. During these periods, the questions of each test are approved among all the participating countries; then they are translated, and later the grades obtained by the students are discussed.
The student has three tests to solve - a single selection test, a written test, and a laboratory test. Each test lasts 4 hours. During these tests, students have questions from the 3 areas: chemistry, physics, and biology.
The Olympiad was held in Thailand, from December 01 to 10, 2023. The Costa Rican delegation was made up of:
Andrea Rivera Álvarez, Head of Delegation and Physics Mentor
Ricardo Ulate Molina, Mentor
Kenneth Castillo Rodríguez, Mentor
Mateo Sancho Dive, Student
Sol Moya Peñaranda, Student
Gabriel Ampie Rojas, Student
Ariana Espinosa Clavera, Student
Sofía Argüello Herrera, Student Achievement: Sol Moya Peñaranda Bronze Medal
134

Support to Companies of Applied Scientific Research
Entrepreneurship: COMPANY
Office of Naval Research Global
ASOPROA Santa Cruz


LANOTEC
Boston Scientific de Costa Rica S.R.L.
Calox de Costa Rica S.A.
Philips Morris
Coopervision Manufacturing
Costa Rica
Alternatives for interface-modified and 2D/3D perovskite absorbers for perovskite solar cell applications
PINN: Generation of agro-industrial capacities and creation of a comprehensive unit (physical-chemical, organoleptic, and microbiological characterization) to improve the production process of Turrialba cheese with Designation of Origin
Material characterization analysis
Material characterization analysis
Design and development of a concept model to establish a bioinformatic study of lung cancer by means of computer vision at nanomolecular-scale 3D images and circulating molecular biomarkers of associated genes.
Evaluation of the impact of cigarette smoke vs THS on indoor air quality
Material characterization analysis
LABORATORY
136
RESEARCH
FIFCO
H2020 - EU - University of Belgrade, Serbia
Hologic Surginal Products
Costa Rica S.R.L.
Proquinal

FIFCO - ISEF
BAC Credomatic
Confluent Medical Costa Rica
Abbot Medical
Nextern
UPL Costa Rica
BIO365
Gutis SRL
Nevro Medical SRL
Mejía Azacarate SRL
Smiths Interconnect SA
AbbVie
Plastic bottle characterization analysis
Automated functional screening of IgGs for diagnostics of neurodegenerative diseases (AUTOIgG)
Material characterization analysis
Evaluation of the antimicrobial activity of four vinyl fabrics produced by the company
Eureka - ISEF Workshop
Promotion of scientific vocations and participation at fairs at the high-school level
BAC credit cards
Material characterization analysis
Material characterization analysis
Material characterization analysis
Material characterization analysis
Material characterization analysis
Material characterization analysis
Material characterization analysis
Material characterization analysis
Material characterization analysis
Material characterization analysis



COMPANY RESEARCH 137

COMPANY
Organic Ecogreen
SAVAL Laboratory
Fertinyc
Private Northern University, Peru
RESEARCH
Workshops and Trainings
Material characterization analysis
Biopolymer prototype, obtained from pineapple biomass waste. (BIO TAG)
Metal nanoparticles biosynthesized from agroindustrial waste applied in the functionalization of bioplastics for use in the berry industrial chain




CENIBiot LABORATORY





COMPANY
Thrive Natural Care
RESEARCH
Preparation, quantification, characterization, and method development for extracts of plant origin materials
Nippon Paper Papylia Co., Ltd.
Coopetarrazú
Biotech C.R. S.A.
Bio CR
In vitro plant establishment and genetic fingerprinting protocols
Preparation, quantification, characterization, and method development for extracts of plant origin materials
Molecular identification (DNA barcoding) of living organisms and development of bioprocess optimization and scaling protocols
Physicochemical quality control analysis for beer
138

Corbana S.A.

Molecular identification (DNA barcoding) of living organisms and development of bioprocess optimization and scaling protocols
Corporación de Desarrollo
Agrícola del Monte S.A.
CoopeAgri R.L.
Speratum
Stein Laboratories
CoopeCUNA
Mammoth Biosciences
Granja Avícola Santa Marta
BaseCamp Research
Molecular identification (DNA barcoding) of living organisms
Quantification of polyphenols
Implementation Unit
Development and validation of quantification and identification methods by HPLC and mass spectrometry techniques

Compund-Foods

Development, quality control, and knowledge transfer for oil production processes at an industrial scale
Description of microbial metagenomes in extreme environments
Optimization of production protocols of organic biological amendment for agricultural use
Large-Scale Microbial Diversity Study in Costa Rica, there is also an agreement with the company to carry out future research projects
Production of metabolites of commercial interest in coffee cell suspensions and improvement of analytical processes and protocols

Treinta y cinco Fábrica de Cervezas
Establishment Labs
Fruitpoint Costa Rica
Osa Conservation


Storage and cryopreservation of microorganisms
Determination of the presence of plasticizers
Freeze-drying of samples (Stock of microorganisms through freeze-drying)
Nucleic acid extraction




Source: Information provided by CeNAT's laboratories for 2023.
COMPANY RESEARCH
139



Support to Applied Scientific Research Organizations or Institutions




INSTITUTION RESEARCH
Ministry of Science, Technology, and Telecommunications (MICITT)
Ministry of Agriculture and Livestock (MAG)
Public Universities (UCR, TEC, UNA, UNED, UTN)
Chamber of Information Technologies (CAMTIC)



CNCA LABORATORY





Advanced Computing System for Latin America and the Caribbean (SCALAC)
Central American Higher University Council (CSUCA)
Collaboration for the development of artificial intelligence in the country
Support to research institutes in the development of activities
Advanced computing platform for the development of research and training projects
Collaboration in the artificial intelligence chapter
Support in the organization of the company structure

Advanced computing platform for the development of research and training projects


140


PRIAS LABORATORY
COMPANY
CONICIT, MICITT, DLR, SINAC, MINAE

FAO, SINAC, MINAE, and other users of the available information
TEC, National Museum, and UTN
SIMOCUTE
CONARE-PEN
RESEARCH
MONEO-WET Project Applicability of Sentinel-2, DESIS, and Landsat 8 satellite imagery data for water quality studies, on water bodies related to crop coverage surroundings of the National Térraba-Sierpe Wetland (MONEO-WET). In addition, he participated in an internship at the German Space Agency
FAO-SEPAL Project: Pilot digital system for monitoring illegal logging in the Golfo Dulce Forestry Reserve and a study area on the Pacific side of La Amistad National Park
Project: Spatialization of the tree flora of Costa Rica pilot study for the Greater Metropolitan Area
Participation in workshops to update the SIMOCUTE classification system
Project, “Cantonal Historical Geospatial Representation of Costa Rica for the 1905-2014 period: Constructing the spatial representation in the form of geographic information layers that enable reproduction of the Territorial Administrative Division of Costa Rica for the periods 1905, 1950, 1963, 1973, 1984 and 2014”.
Project, “Local productive structures: productive, labor, and territorial value chains in Costa Rica”
141
Regional Science and Technology Advisory Group (RSTAG)
Municipality of San José, INEC RedClara

Aerospace Engineering Group
UNED-LIIT

MTF Teak
Participation at work sessions and workshops carried out by different representatives on the topic of disasters and risk reduction
Collaboration opportunity for the calculation of SDG indices
Through RedCLARA, the PRIAS laboratory is invited to participate in a webinar on the Copernicus program initiative in Latin America, the Ideaton BELLA is held to promote innovation projects related to Earth Observations

ENAPROC, Mexico
Sevilla University
Project: Reforestation from the air: Methodology to evaluate the effectiveness of reforestation with rocketry as a dispersion mechanism
Project on the forest fire regime in Costa Rica, possible strategies for mitigating their impact on the tropical dry forest
Spectral Signature Library Project: Study
Integration of the use of remote and in situ sensors for the detection of pests and diseases in Tectona grandis Lf plantations in Nandayure, Guanacaste Costa Rica
Community Capabilities Initiative
Bothrops asper

Opportunities for collaboration, among which a framework agreement has been valued, to support the survey of spectral signatures of Salinas

COMPANY RESEARCH 142
ENVIRONMENTAL MANAGEMENT

COMPANY RESEARCH
MICITT
FUNDECOOPERACIÓN
OEI
IEO – OECD
CONARE – GlobalEdu –Procomer
FunCeNAT – CINDE IMN
IDB
Desamparados Development Association – UNED – UCR
Apoyo a realización de talleres de formación en propuestas de la Unión Europea
Participación en actividad de cierre del mes de la Ciencia, con Stand
Participación en actividad de presentación de proyectos ADAPTA2 en la Antigua Aduana
Noche Iberoamericana
Desarrollo taller paralelo a Reunión Ministerial Latinoamericana de Ministros de Ambiente de la OCDE
Desarrollo Stand Costa Rica CAEI-2023 en Las Vegas
Proyecto BID – Biomateriales
Proyecto BID – Biodesarrollos
Búsqueda de fondos para lanzamiento de sondas meteorológicas, en el marco del PIACT
Presentación de propuestas de investigación en temas de variabilidad y cambio climático
Observatorio de Salud Ambiental de Desamparados
Source: Information provided by CeNAT's laboratories for 2023.
143

For Centro Nacional de Alta Tecnología, the socialization of scientific knowledge is very relevant. It is carried out through subsystems such as scientific education, communication, and dissemination of the institutional work of CeNAT.


CeNAT works for society and therefore communication is a bridge with the population to disseminate scientific knowledge and the findings made by the laboratories and the Area.
The communication work that is carried out entails the attention of the press and solving queries from the population on the social networks.
145
Work of CeNAT on Media

CeNAT's Social Networks
Currently, presence on social networks is essential under the dissemination strategy, it is a permanent communication channel that has the advantage of the immediacy of the information with the institution's audiences. CeNAT has a YouTube channel, a Soundcloud account, a Facebook page, and a website, which represent the institutional channels. They provide information to the different segments.
Valuable informative and educational content is published on CeNAT’s networks, which contributes to promoting scientific vocations.
The posted content includes announcements of virtual courses or workshops, news of institutional work, CeNAT-CONARE scholarship programs, knowledge transfer activities, research projects, and digital campaigns that are launched on several topics.
Within the digital ecosystem, the Facebook page maintains constant growth in followers, with an audience stratified into 53.70% women and 46.30% men.

Digital media 20 Written press 10 Radio Television 9 11 @
146




Para el 2023 se desarrollaron tres campañas:
Becas CeNAT-CONARE, proyectos de Investigación de las dependencias y Aniversario CeNAT








147

15 THOUSAND MORE THAN
Number of followers
45,000 people
Average monthly reach of posts

Work of CeNAT on Media


14 THOUSAND
MORE THAN likes to the page 49
Number of countries that follow the page
Source: information for the year 2023 provided by CeNAT Communication.
* The number of followers has been generated organically, without resorting to paid social media advertising.
**As of December 31, 2023
149
Argentina
Australia
Austria
Belgium
Bolivia
Brazil
Canada
Chili
Colombia
Costa Rica
Cuba
Czech Republic
Denmark
Dominican Republic
Ecuador
Egypt
El Salvador


Source: Information from the year 2023.
France
Germany
Guatemala
Honduras
Iraq
Israel
Italy
Japan
Mexico
Netherlands
New Zealand
Nicaragua
Nigeria
Norway
Panama
Paraguay
Peru
Philippines
Portugal
Puerto Rico
Russia
South Korea
Spain
Sweden
Swiss
Syria
Türkiye
United Kingdom
Uruguay
USA
Venezuela
Vietnam


Countries that follow CeNAT's activities socialized on Facebook
150

The main data of information on reach, achievements and impacts evidenced by each of the Laboratories of CeNAT in the year 2023 are presented below.
Human Resources at CeNAT
Centro de Alta
Tecnología Foundation
Officers, collaborators and scholarships.
Period 2023-2022
YEAR 2023 255
Officers
Collaborating students Scholarships Total
Source: Information on the year 2023 provided by the Laboratories and Area of CeNAT.
ORIGIN
YEAR 2023 69 141 45 255 YEAR 2022 78 145 41 264 Variation % -13% -3% 9% -4%
151


Source: Information on the year 2023 provided by the Laboratories and Area of CeNAT.
160 140 120 100 80 60 40 20 0 Officers, collaborators and scholarships 69 Officers Año 2023 Año 2022 Collaborating students Scholarships 78 -13% -2% 141 145 45 41 -3% 152

2023 Indicators, according to CeNAT Laboratories and Areas
Source: Information on the year 2023 provided by the Laboratories and Area of CeNAT.
C eNAT Public and private indicators 2023 Indicator CNCA PRIAS GA LANOTEC CENIBiot Total Publications 12 4 2 33 15 66 Knowledge transfer 51 16 20 40 30 157 Projects 15 11 7 36 26 95 Cluster Performance Days 365 - - - - 365 Cluster usage hours 85,363 - - - - 85,363 Agreements 3 3 2 4 2 14 Student support 16 14 11 64 72 177
153





Source: Information on the year 2023 provided by the Laboratories and Area of CeNAT.
12 51 15 3 16 4 16 11 3 14 2 20 7 2 11 33 40 36 4 64 15 30 26 2 72 0 50 100 150 200 250 300 350 400 Publications Knowledge transfer Projects Agreements Support to students CNCA PRIAS AGA LANOTEC CENIBiot 154
Sectors linked to CeNAT in the Last Six Years








Education 2018 Social 2018 Health 2018 Energy 2018 Agriculture 2018 Local-Municipalities 2018 Aerospace 2018 Tourism 2018 Environmental 2018 Food 2018 Technology 2018 National Security 2018 Medical Physics 2018 Biodiversity 2018 Drug development 2018 Biorefinery/Bioeconomy 2018 Medical Devices 2018 Aeronautics 2018 Accreditation 2019 Art and Culture 2019 Sports 2019 Textile 2019 Transportation 2020 Marine-fishing Ministry of Treasury 2021 Regulation 2021 2021 Forest 2021 Innovation 2021 Banking and finances 2022 Economy 2023
Analysis of the information provided by CeNAT's laboratories, updated to December 2023.
Identi cation of sectors related to CeNAT as of December, 2023 155
Source:
Institutions that Started Relations with CeNAT in 2023







Source: Analysis of the information provided by CeNAT's laboratories, updated to December 2023.

 Centro Nacional de Alta Tecnología CeNAT
Ministry of Treasury
MICITCONICITT
LANAMNE
MEIC MINAE Civil Aviation
CCSS Procomer
M. RREECancillería Banco Popular
Estado de la nación
ECALACOMET
MEP
COMEX
BCCR MAG INEC
INA Recope
CINDE
CNFL
ICE
SENARA Aqueducts and Sewage AyA
Ministry of Justice
Inst. Nat. Innovation and Technology Transfer. Agriculture
Min. of the Presidency
Min. of Public Security Professional Guilds Public Universities
Centro Nacional de Alta Tecnología CeNAT
Ministry of Treasury
MICITCONICITT
LANAMNE
MEIC MINAE Civil Aviation
CCSS Procomer
M. RREECancillería Banco Popular
Estado de la nación
ECALACOMET
MEP
COMEX
BCCR MAG INEC
INA Recope
CINDE
CNFL
ICE
SENARA Aqueducts and Sewage AyA
Ministry of Justice
Inst. Nat. Innovation and Technology Transfer. Agriculture
Min. of the Presidency
Min. of Public Security Professional Guilds Public Universities
156
Ministry of Housing and Human Settlements (MIVAH)










Source: Analysis of the information provided by CeNAT's laboratories, updated to December 2023.
Institutions, Organizations, and Companies Linked to CENAT in 2023 CeNAT MEIC MINAE MAG ICE INA Civil Avia�on ECA-LACOMET INEC CCSS Ministerio de Jus�cia ICT Chamber Professional Guilds SENASA SCALAC MEP MICITT CONICIT BCCR CSUCA ICAFE CORFOGA CANAPALMA COMEX CINDE Procomer CANAPEP Chamber of Tourism Banco Popular CNFL Ministry of Treasury US Naval Chamber of Industries Bri�sh Columbia University UCIMED Meryland University NASA Servir NATGEO JUPEMA Liberty AMEXCID ENAPROC CoopeAgri CoopeVictoria Red Educadores Ambientales Incorporated in 2020 Incorporated in 2019 Incorporated in 2018 Incorporated in 2021 Present in 2023 Incorporated in 2022 Inst. Nat. Innova�on and Technology Transfer. Agriculture Ministry of Housing and Human Se�lements (MIVAH) Meteorological Ins�tute Ministry of Health Public universi�es Associa�on of Agronomists 000
Perception of what the institutions have done with CeNAT
Source: Analysis of the information provided by CeNAT's laboratories, updated to December 2023.
 Scientific publication
Cooperation / collaboration
Management efficiency
Social Outreach
Interuniversity cooperation
Work quality
Strategic Alliances
Innovation and development
Strategic solutions
Scientific services
Articulating entity
Scientific publication
Cooperation / collaboration
Management efficiency
Social Outreach
Interuniversity cooperation
Work quality
Strategic Alliances
Innovation and development
Strategic solutions
Scientific services
Articulating entity
158
Scientific designs
CeNAT
Expectations of Institutions from
CeNAT at the forefront of research
CeNAT as an ally to meet institutional objectives
CeNAT supports country goals
CeNAT supports reliability of the data
CeNAT in the development of joint projects
CeNAT in scientific training
CeNAT in institutional relation strengthening

CeNAT as an innovative institution
CeNAT conducting joint research
CeNAT is closer to the academy
CeNAT as organizer of scientific events
CeNAT in participation in international projects
CeNAT in joint publications
CeNAT in solutions to global problems
CeNAT socializes the use of information
Source: Analysis of the information provided by CeNAT's laboratories, updated to December 2023.
CeNAT as support to the productive sector
CeNAT in municipal collaboration
CeNAT as support in purchasing services
CeNAT as Prototyping support
CeNAT in community projection
CeNAT in institutional projection
CeNAT in scientific publications
CeNAT in scientifically-correct relationship
CeNAT in PINN-funded services
CeNAT with permanent relationship
CeNAT in upscaling of technology transfer
CeNAT in research projects
CeNAT does not compete for research funds
CeNAT as strategic partnerships
CeNAT in effective collaborations
Centro Nacional
159

Figure 8. World Map of the Scope of CeNAT in 2023








Source: Analysis of the information provided by CeNAT's laboratories, updated to December 2023.


160

Table 1. World Map of the Scope of CeNAT's Laboratories in 2023
Source: Analysis of the information provided by CeNAT's laboratories, updated to December 2023.
Germany Argentina Australia Belize Brazil Canada Chile China Colombia Ecuador El Salvador Spain U.S. France Guatemala Honduras England Israel Italy Japan Mexico Nicaragua Panama Peru UK Serbia Switzerland Turkey Uruguay Venezuela
CENIBIOT X X X X X X X X X X X X X X X X LANOTEC X X X X X X X X X X X X Environmental Management X X X X X X X X X X X X X X X X X X PRIAS X X X X X X X X X X X X X X X CNCA X X X X X X X X X X X X X X X X X X 161


Impact Reached in 2023 at CeNAT



5
7
2
THOUSAND MORE THAN 45,000 PEOPLE Facebook Followers Average annual reach of Facebook posts 49 Nationalities of Facebook followers 50 Presence in the media
15
Registered patents
Registration processes
Researchers in the United States Invention Registration
163



66 Scientific Publications

177 Students in academic scientific development projects
95 Projects developed within the triple-helix framework: Academic, Government, and Private Sector

45 Scholarships within the framework of the CONARE-CeNAT Scholarship Program

365 days of cluster operation
634 accounts with access to computing infrastructure services
85,363 science hours in simulations and data processing
157 Knowledge transfers taught
9,963 Benefited population
7 Olympiad and fairs supported
Impact in 2023
164
9,000




5 Eduroam deployed in the campuses of the 5 Public Universities
6 network services available to students, staff, and teachers
157,316 students and professors of public universities with access to the Edu-Roam network
105 Countries with Eduroam
7.5 billones logins to the Eduroam Network from international territories

Source: information for the year 2023 provided by CeNAT Communication.

technical assistance to producers in Variability and Climate Change 28 support to applied scientific research organizations or institutions 45 support to applied scientific research companies 26 linkage with strategic sectors 14 agreements 29 linkage with inter-institutional networks
Countries linked to CeNAT
30
165

FunCeNAT and Financial Results
The Centro Alta Tecnología Foundation (CeNAT Foundation -FunCeNAT) was created by Act No. 7806, of May 25, 1998, with the purpose of managing the resources and attention of the institutional goals of the Centro Nacional de Alta Tecnología (CENAT).
Article 3.- The State and its institutions are hereby authorized to transfer resources to the Centro Nacional de Alta Tecnología, whose administration and management will be handled by the Fundación Centro Alta Tecnología.
FunCeNAT is under continuous supervision by the Comptroller General of the Republic, with regard to the proper management and administration of the resources received under the Act 7386. In the same way, it is audited continuously by CONARE Audit Department, in addition to third-party annual audits.

as the entity that would hold the legal duty to administer the resources required for the execution of the projects developed through CeNAT.
Furthermore, the Foundation has a Board, comprised by representatives of the State Institutions of University Higher Education (IESUE), the local city government (Municipality), and of the Government of the Republic. The Board appoints an Executive Director in charge of FunCeNAT.
It worth mentioning that at the time of creating CENAT, within the legal context, the chancellors of the universities that are members of CONARE, also created the Centro de Alta Tecnología Foundation (FUNCENAT). This foundation addresses the special characteristics of CENAT in aspects related to its structure and the legal regime provided. Law No. 7806 of May 25, 1998 expressly recognized FunCeNAT
The Foundation acts as a service platform that meets the needs of CeNAT, as well as the public and private projects it manages. For this reason, FunCeNAT actively collaborates in the work of the areas, laboratories, programs and projects, providing support in administrative management in an efficient and transparent way, in sound financial management, in the organizational development at national and internationals, as well as legal support in the actions that the Laboratories, Programs and Projects undertake. Through its work, it strengthens the link with CONARE, in addition to supporting communication and inter-sectoral articulation.
167




below.


It always aligns all its activities with the guidelines issued by CONARE, its Board of Directors, the Comptroller General of the Republic, and the audit of CONARE, as well as the External Audit, so that its activities and actions comply with all the applicable laws and regulations.
FunCeNAT is the foundation that provides permanent support to CeNAT laboratories and programs in four pillars for organizational development, namely:






Administrative Management Legal Management Human Talent Management Financial Management and Fundraising
Science and Engineering of Materials Biotechnology Advanced Computing Environmental Management Science, Culture and Society Administrative Management Financial Management and Fundraising Organizational Development Management Legal Management LANOTEC CENIBiot CNCA
Agromatics Climate Observatory
CeNAT Executive Management FunCeNAT FunCeNAT
PRIAS
General Director of CeNAT
Board of Directors FunCeNAT 168
The operational structure of CeNAT showing its workflow is presented

REPORT OF THE INDEPENDENT AUDITORS ON THE SUMMARY FINANCIAL STATEMENTS
To the Managing Board of Fundación Centro de Alta Tecnología (FunCeNAT) .
The summary financial statements, which comprise the summary statement of financial position as of December 31, 2023, and the summary income statement for the year then ended, as well as the corresponding explanatory notes, are derived from the audited financial statements of the Centro de Alta Tecnología Foundation - FunCeNAT (“the Foundation”) for the year ended on December 31, 2023. In our report dated March 19, 2024, we expressed a n unmodified audit opinion on these financial statements Th ose financial statements, and the summary financial statement s, do not reflect any effects of events that occurred subsequent to the date of our report on those financial statements
The summary financial statements do not contain all the disclosures required by the International Financial Reporting Standards for Small and Medium Enterprises for the preparation of the audited financial statements of the Centro de Alta Tecnología Foundation (FunCeNAT). Consequently, reading the summarized financial stat ements is not a substitute for reading the audited financial statements of the Centro de Alta Tecnología Foundation (FunCeNAT).
Management's responsibility for the summary financial statements
Management is responsible for the preparation and reasonable presentation of the financial statements, in accordance with the International Financial Reporting Standards for Small and Medium-sized Enterprises and for any internal control that Management ma y deem necessary to allow for the preparation of financial statements that are free from material errors, both due to fraud and mistakes not related to fraud.
Auditor's responsability
Our responsibility is to express an opinion on whether the summary financial statements, based on our procedures performed in accordance with the International Standard on Auditing (ISA) 810 “Engagements to report on Summary Financial Statements.”


DC-ALLIANCE Public Accountants Firm Santo Domingo, Heredia P O Box 128-3100 +506-88391469. +506-88359996.
170

Opinion
In our opinion, the summary financial statements derived from the audited financial statements of the Centro de Alta Tecnología Foundation (FunCeNAT) for the year ended December 31, 2023, are consistent, in all material respects with those financial statements, in accordance with International Financial Reporting Standards for Small and Medium Enterprises
Ms. Zorahyda Vargas V.- C.P.A. No. 4204
Policy No.0116 FIG 7
Expiration: September 30, 2024
Tax Stamp No.6663, ¢1,000
Paid and affixed to the original document
March 19, 2024


DC-ALLIANCE Public Accountants Firm Santo Domingo, Heredia P O Box 128-3100 +506-88391469. +506-88359996.
171




SUMMARY STATEMENTS OF FINANCIAL POSITION AS OF DECEMBER 31, 2023 AND 2022 AND JANUARY 1, 2022 (Restructured) (Figures Expressed in Costa Rican Colones)




DE ALTA TECNOLOGIA FOUNDATION (FunCeNAT)
CENTRO
2023 2022 (Restructured) 01/01/2022 (Restructured) ¢ 102,938,521 ¢ 17,356,247 ¢ 131,407,809 457,638,814 260,273,653 524,474,251 20,066,474 21,829,069 18,363,673 17,743,157 34,489,650 62,984,189 598,386,966 333,948,619 737,229,922 1,845,873,090 1,886,650,771 2,064,571,557 824,892 1,376,346 1,927,800 ¢2,445,084,948 ¢2,221,975,736 ¢2,803,729,279 ¢ 125,506,227 ¢ 39,692,996 ¢ 63,650,571 1,435,815,380 1,361,793,396 1,750,419,058 655,443,141 634,485,777 753,191,011 2,216,764,748 2,035,972,169 2,567,260,640 186,003,567 236,468,639 209,805,870 42,316,633 (50,465,072) 26,662,769 228,320,200 186,003,567 236,468,639 ¢2,445,084,948 ¢2,221,975,736 ¢2,803,729,279 ASSETS CURRENT ASSETS Cash and Cash Equivalents Investments held to maturity Interest receivable on investments Accounts Receivable TOTAL CURRENT ASSETS Investments held to maturity Computer equipment, net TOTAL ASSETS NET LIABILITIES AND ASSETS LIABILITIES Accounts payable and accumulated expenses Restricted Public Funds Restricted Private Funds TOTAL LIABILITIES NET ASSETS Accumulated Surpluses Surplus or (deficit) of the period Total Current Assets TOTAL LIABILITIES AND NET ASSETS 172


2023 2022 (Restructured) CENTRO DE ALTA TECNOLOGIA FOUNDATION (FunCeNAT)
FOR THE YEARS ENDING DECEMBER 31, 2023 AND 2022 (Restructured) (Figures Expressed in Costa Rican Colones) REVENUE: Interest on investments ¢ 74,466,899 ¢67,407,535 Project Management Interest 146,502,142 35,377,076 Total Revenue 220,969,041 102,784,611 EXPENSES: General and administration expenses 159,185,419 165,643,607 Foreign exchange differences, net 19,548,373 (3,511,989) Other expenses/income (81,384) (8,881,935) Subtotal 178,652,408 153,249,683 SURPLUS (LOSS) FOR THE PERIOD ¢ 42,316,633 ¢ (50,465,072) 173
SUMMARY INCOME STATEMENTS




Consejo Nacional de Rectores


Dr. Emmanuel González Alvarado
Dr. Gustavo Gutiérrez Espeleta
Chancellor, University of Costa Rica
María Estrada Sánchez MSc.
MSc., Chancellor, Costa Rica Institute of Tecnology
Francisco González Alvarado
M.Ed., Chancellor, National University
Rodrigo Arias Camacho Chancellor, National Technical University
MBA., Chancellor, State University for Distance Education


175
Scientific Council
Lilliana Rodríguez Barquero
M.Sc. National Technical University
Dr. María Laura Arias Echandi
University of Costa Rica
Dr. Floria Roa Gutiérrez
Costa Rica Institute of Tecnology
Dr. Ing. José Luis León Salazar
Eng. Costa Rica Institute of Tecnology
Dr. Jorge Herrera Murillo
National University
Dr. Rosibel Víquez Abarca
PhD. State University for Distance Education


176

Strategic Partners







University of Costa Rica
Costa Rica Institute of Technology





National University
Universidad Estatal a Distancia (State Distance Education University)

National Technical University
Costa Rican Promoter of Innovation and Research
MICITT
177






Centro de Alta Tecnología Foundation

President: Rodrigo Arias Camacho, MBA
Secretary: Dr. Emmanuel González Alvarado
Treasurer: Dr. Gustavo Gutiérrez Espeleta
Board Member 1: Rose Marie Ruiz Bravo
Board Member 2: Marielos Aldi Villalobos

First Comptroller: Jorge Chaves Arce
Second Comptroller: Francisco González Alvarado, MBA
CeNAT Director: Eduardo Sibaja Arias, Eng.
OPES-CONARE- Legal Advisor: Mr. Gastón Baudrit Ruiz

178
Directorate of CeNAT

Eduardo Sibaja Arias
Eng., Director, CeNAT
Karol Palma Odio
Administrative Assistant




Dr. José Vega Baudrit
Director, National Nanotechnology Laboratory
Dr. Randall Loaiza Montoya
Director, National Center for Biotechnological Innovations
Dr. Esteban Meneses Rojas
Director, National Collaboratory of Advanced Computing
Allan Campos Gallo
Laboratory Directors
Eng., Director Environmental Management Area
Cornelia Miller Granados
Eng., PRIAS Laboratory Director
179
Officers

CeNAT
Melinda Corrales Ramírez
Rubén Padilla Hernandez
Sugey Rivera Obando
Andreina Leal Sánchez
Fabián Ramírez Villalobos
CeNAT- Environmental Management
CeNAT
CeNAT
CeNAT
CeNAT-PRIAS
180


Rebeca Rodríguez Fonseca
Charys López Borbón

Anthony Mayorga Hernández



LANOTEC



Fabiola Rodríguez Ulloa
Andrea Araya Sibaja
Diego Batista Menezes
Gabriela Montes de Oca Vásquez
Juan Miguel Zúñiga Umaña
Melissa Camacho Elizondo
Reinaldo Pereira Reyes
Rebeca Corrales Brenes
Sergio Paniagua Barrantes
Yendry Corrales Ureña
Susana Mesén Porras
Claudia Chaves Villarreal
Daniela Zúñiga Rivera
Andrea Rivera Álvarez
181

CNCA

Melissa Hernández Sánchez
CNCA
Fabricio Quirós Corella
CNCA
Carlos Gamboa Venegas
CNCA-CONARE NETWORK
Melany Calderón Osorno
CNCA-CENIBiot
Edward Soto Castro
CNCA
Christian Asch Burgos
CNCA
Herson Mena Mora
CNCA
Johansell Villalobos Cubillo
CNCA
Isaí Ugalde Araya
CNCA-CONARE NETWORK


182

PRIAS

Heileen Aguilar Arias
Iván Ávila Pérez
Stephanie Leitón Ramírez
Milagro Jiménez Rodríguez
Christian Vargas Bolaños
Mariana Ávila Ruiz
Jose Umaña Ortiz
Fabián Ramírez Villalobos PRIAS PRIAS PRIAS PRIAS PRIAS PRIAS PRIAS CeNAT-PRIAS
183

CENIBiot


Max Chavarría Vargas

Emmanuel Araya Valverde
Pamela Alfaro Vargas
Jose Pablo López Gómez
Jonathan Parra Villalobos
Vanessa Maria Rivera Mora
Rachel Ardón Rivera
Erika Barrantes Murillo
Silvia Elena Fernández Fernández
Melissa González Sanabria
Valeria Leandro Arce
Cristofer Orozco Ortiz
Natalin Picado Canales
Douglas Alberto Venegas González


Daniela Wicki Emmenegger
Yosimar González Fernández
Alina Gamboa Villalobos
Esteve Mesén Porras
Luis Diego Hidalgo Badilla
María Paula Valverde Mora
Isaac Delgado Quirós
Katherine Alfaro Bolaños
Jonathan Cortés Oviedo
Melany María Calderón Osorno




184
Program Coordinator


Patricia Sánchez Trejos Agromatics, Food Safety And Slow Food
Jazmín Calderón Quirós

State of the Nation
Gustavo Rojas Godínez
Erick Rojas Zuñiga
Maria Camila Aguilar Gomez
Sebastián González Rosales
José Mario Achoy Sánchez
185
FunCeNAT
Cynthia Cordero Solís Administrative Director
Mauricio Segura Chacón
Jeannette Vargas Arce
Yakelyn Bejarano López
Margarita Quan Zepeda
María Fernanda Hernández Jiménez
Carolina Morales Cerdas

Paula Valverde Mora


186
Scholars and Collaborators
Sheila Jiménez Mesén
Valeria Rojas Chinchilla
Antony Torres Solano
David Araya Gutiérrez
Dilan Rojas Saborío
Geisel Cabrera Lazo
Johana Valera Rangel
Lucia Noboa Jiménez
Randall Hidalgo Sánchez
University of Costa Rica (UCR)
National University of Costa Rica (UNA)
University of Costa Rica (UCR)
Costa Rica Institute of Technology (TEC)
National University of Costa Rica (UNA)
National University of Costa Rica (UNA)
University of Costa Rica (UCR)
University of Costa Rica (UCR)
University of Costa Rica (UCR)
CENIBiot
CENIBiot
CENIBiot
CENIBiot
CENIBiot
CENIBiot
CENIBiot
CENIBiot
CENIBiot

Carlos Pasquier Jaramillo
Eduardo Aguilar Bejarano
Esteban Bertsch Aguilar
Dorian Rojas Villalta
Isaura Gutiérrez Vargas
Julián Sánchez Castro

University of Costa Rica (UCR)
University of Costa Rica (UCR)
University of Costa Rica (UCR)
Costa Rica Institute of Technology (TEC)
University of Costa Rica (UCR)
Costa Rica Institute of Technology (TEC)
CNCA CNCA CNCA CNCA CNCA CNCA 187



Andrea Rivera Álvarez
Fiorella Calderón Jiménez
Karina Ramírez Monge
Vanessa Morales Cerdas

University of Costa Rica (UCR)
Costa Rica Institute of Technology (TEC)
University of Costa Rica (UCR)
University of Costa Rica (UCR)




Ana Carlota Reyes Rufino
Estefanie Tatiana Grant Rogers
Jean Carlo Guerrero Piña
Keylan Simmons Coto
Ricardo Quesada Grosso
Lisa Stephanie Badilla Vargas
Karina Ramírez Monge
Paola Sanchez Navarro

University of Costa Rica (UCR)
University of Costa Rica (UCR)
Costa Rica Institute of Technology (TEC)
University of Costa Rica (UCR)
University of Costa Rica (UCR)
University of Costa Rica (UCR)
University of Costa Rica (UCR)
University of Costa Rica (UCR)

LANOTEC
LANOTEC
LANOTEC
LANOTEC
LANOTEC
LANOTEC
LANOTEC
LANOTEC
Javier Chinchilla Orrego
Jordan Hernández Ledezma
Luis Diego Mora Araya
Sebastián Moya Salas
Laura Rojas Artavia

Karen Salazar Barrantes
Michael Solano Rojas
University of Costa Rica (UCR)

National University for Distance Education (UNED)
University of Costa Rica (UCR)
University of Costa Rica (UCR)
University of Costa Rica (UCR)
University of Costa Rica (UCR)
University of Costa Rica (UCR)


LANOTEC
LANOTEC
LANOTEC
LANOTEC
LANOTEC
LANOTEC
LANOTEC

EM EM EM EM
188

Fabiola Solano Cerdas
Shirley Méndez Cordonero
Andrea Hidalgo Piedra
Hanzel León González
Róger Hernández Jiménez
Michael Quesada Valverde
Adolfo Piedra Mora
Brayan Rodríguez
Costa Rica Institute of Technology (TEC)
National University of Costa Rica (UNA)
University of Costa Rica (UCR)
Costa Rica Institute of Technology (TEC)
University of Costa Rica (UCR)
University of Costa Rica (UCR)
University of Costa Rica (UCR)
National University for Distance Education (UNED) PRIAS PRIAS PRIAS PRIAS PRIAS PRIAS PRIAS PRIAS
189
TEAM MEMBERS
CENIBiot

Verónica Ramos Salazar
María Torres Hidalgo
Jazmín Calderón Quirós
Hazel Alvarado Pérez
Darling Mora Rojas
Daniela Lai Sánchez
Camille Bernand-Pardell
Brayan Villalobos Quintanilla

Bayron Leiva Gamboa
Paula Chiví Ramírez
Luis Hidalgo Badilla
Dessiré Arrieta Murillo
Yili Liang Wu
Alison Salas Campos
Montserrat Mendoza Salas
Michelle Montero Quesada
Jonathan Sánchez Vargas
Andrés Hernández León
Daniela Viquez Espinosa
Maria Paniagua Rojas
Maricruz Monge Mora
Alexis Jerez Navarro
Esteban Escalante Campos
Andrea Calvo Obando
Sofía Trejos Valverde
Ariana Herrera Quesada
Bethania Zamora Zuñiga
María Henríquez Granados
Mauro Jimenez Gonzalez
Diana Vargas Hernández
Noelia Rechnitzer Sandí
Priscila Campos Astorga
Andrés González Vega
Victor Viquez Muñoz
Sharon Chacón Vargas
María Gómez Bogantes
Allan Artavia León
Ashelee Sosa Cordero
David Morera Uribe
Karla Montero Castro
Raquel Jiménez Umaña
Meilsey Godínez Portuguez
Cristopher Arguello Rivera
Ariel Arroyo Chaves
Diógenes López Barrantes
Juan Ignacio Garro Rodríguez
Kevin Segura Rodríguez
Mariana Campos Hernández
Montserrat Mendoza Salas
Ashly Bolaños Umaña
Kenneth Solís Morales
Andrés Abarca Herrera
Karol Aguilar Guerrero
Michelle Montero Quesada
Adrián González Jiménez
Jennifer Calvo Alemán.
Mariana Elizondo Blanco
Alexander Monge Zuñiga
Monzerrat Sánchez Salas
Efraín Escudero Leiva
190
CNCA

José Daniel Amador Salas
Kevin José Facey Torres
Josef Ruzicka González
Dorian Rojas Villalta
Adrián González Jiménez
Antonio Piedra Pacheco
Fernando Herrera Valverde
Mariel Chacón Sánchez
Danniela Cartín Quesada
Juan Pablo Ureña Madrigal

Environmental Management
Jazmín Calderón Quíros
Daniel Serrano Delgado
Miranda Sánchez Zamora
Jazel Domínguez Alvarado
Siony Calvo Brenes
Mirsa Domínguez Alvarado
Marina Ortega Gutiérrez
Martha Montero Vindas
Wenfry Grijalba Villegas
191
LANOTEC

Mauricio Vallejo
Michelle Gutiérrez Campos
Mónica Alfaro Porras
Sara Montero Vargas
Christopher Arguello Rivera
Amanda Sofia Calderón Campos
Catalina Alvarado Jiménez
Ernesto Villegas Villegas
Jeshua Acuña Matamoros
José Pablo Chávez Pérez
Juan Pablo Carballo Gonzales
Kolleen María Alvarado Rodríguez
Tracy Cambronero Sibaja
Valery Torres Garita
Paola Céspedes Ajún
María Francinie Guevara Hidalgo
Esteban Mena Porras
Annaby Contreras Aleman
Dennise Paola Murillo Sojo
Gabriel Abarca Hidalgo
Andrés Chinchilla Velhagen
Jimena Arias Ulloa
Jose Alejandro Rojas Hidalgo
Isaac Portobanco Villalobos
Jose Pablo Alvarado Espinoza
Julián de Jesús Morales Monge
Sergio Bernabé Velásquez Garnica
Alejandro Ureña Clarke
Kevin Segura Rodríguez
Sara Cordero Fuentes
Iván Solís Sandí
Yeymi Torrez Sequeira
Fabricio Chaverri Segura
Andrea Rivera Álvarez
Tamara Quesada Soto
Daniela Zúñiga Rivera
Kenia Blandón Bolaños
Camilo José Zapata Segura
Sergio Solano Calderón
Christopher Murillo Bolaños
Carlos Valenciano Elizondo
Daniel Esteban Rojas Pérez
Daniel Portuguez Molina
Steven David Ceciliano Castro
Nicole Vílchez Mejías
192

PRIAS
Andrés Aguilar Carboni
Manuel Calderón Rodríguez
Natalia Martínez Rojas
ESTADO DE LA NACIÓN
Marines Álvarez Fallas
Ludwing Hall Romero
Yahaira Araya Porras
Stephanie Castro Jiménez
Aaron Barquero Salas
Mario Cortés Vásquez
Kevin Mora Ávila
Christian León Trigueros
Andrea Marín Bolaños
Lisbeth Bonilla Cruz
Walter Pereira Vargas
Luis Gamboa Calvo
Lucía Elizondo Sancho
Fabiana Conejo Arias
Juan Ignacio Sandoval
193



1.3 Km North of the US Embassy, Pavas, San Jose, Costa Rica (506) 2519-5835 | Fax: (506) 2232-0423 cenat@cenat.ac.cr www.cenat.ac.cr /centro.nacional.de.alta.tecnologia Transforming Knowledge Centro Nacional de Alta Tecnología into Development REPORT CeNAT 2023

Scientific publication
Cooperation / collaboration
Management efficiency
Social Outreach
Interuniversity cooperation
Work quality
Strategic Alliances
Innovation and development
Strategic solutions
Scientific services
Articulating entity
Scientific publication
Cooperation / collaboration
Management efficiency
Social Outreach
Interuniversity cooperation
Work quality
Strategic Alliances
Innovation and development
Strategic solutions
Scientific services
Articulating entity